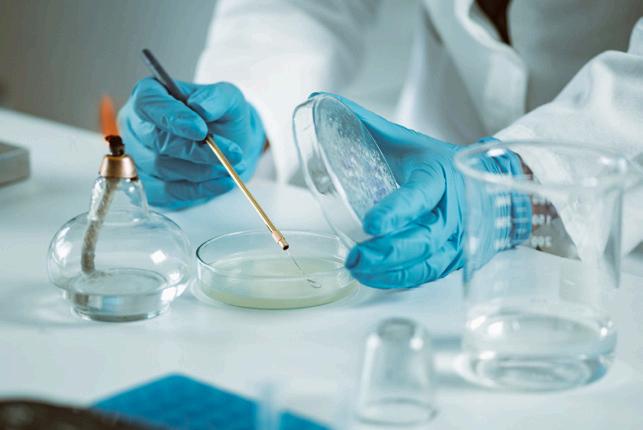

cuairt ar Europass inniu!
#AnChéadChéimEile
Europass today!
#TakeTheNextStep
Tabhair cuairt ar Europass inniu!
#AnChéadChéimEile
Visit Europass today!
#TakeTheNextStep
![]()










cuairt ar Europass inniu!
#AnChéadChéimEile
Europass today!
#TakeTheNextStep
Tabhair cuairt ar Europass inniu!
#AnChéadChéimEile
Visit Europass today!
#TakeTheNextStep
An bhfuil tú réidh uirlisí agus
An bhfuil tú réidh uirlisí agus
acmhainní SAOR IN AISCE a aimsiú maidir leis an bhfoghlaim agus le dul ag obair san Eoraip?
acmhainní SAOR IN AISCE a aimsiú maidir leis an bhfoghlaim agus le dul ag obair san Eoraip?
Are you ready to discover FREE tools and resources for working and learning in Europe?
Are you ready to discover tools and resources for and learning in Europe?

Tabhair cuairt ar Europass inniu!
Arna chomhchistiú ag an Aontas Eorpach
#AnChéadChéimEile
Co-funded by the European Union
Visit Europass today!
#TakeTheNextStep
An bhfuil tú réidh uirlisí agus acmhainní SAOR IN AISCE a aimsiú maidir leis an bhfoghlaim agus le dul ag obair san Eoraip?
Arna
Co-funded by the European Union
Are you ready to discover FREE tools and resources for working and learning in Europe?
europass.europa.eu
An bhfuil tú réidh uirlisí agus
acmhainní SAOR IN AISCE a aimsiú maidir leis an bhfoghlaim agus le dul ag obair san Eoraip?
Are you ready to discover FREE tools and resources for working and learning in Europe?

Editor: Niall Gormley
Production: Michael Farrell
Publishers Ard Education Ltd. T: 01 832 9246 E: ardeducationltd@gmail.com www.educationmagazine.ie
Design Real Issues 086-8986827
Printers W&G Baird Ltd
At the time of press information in Education is believed to be accurate and authoritative. However, some information may change due to circumstances beyond our control. Acceptance of advertisements, does not constitute an endorsement of products or services by the publishers.
© 2024. All rights reserved. Reproduction in whole or in part without permission is prohibited. ISSN 0791-6161

4 N EWS: Retrofit energy programme for five counties; Hidden costs of education revealed in CCPC survey
5 NEWS: Bí Cineálta procedures to prevent and address bullying behaviour announces; Summer Programme increase
7 NEWS: Medical devices review calls for immediate action on unfair biases to prevent patient harm
8 NEWS: Reports map the future of Irishmedium education outside of the Gaeltacht; AvCon 2024 – The Future of Aviation
9 County Museum Dundalk - a secret worth sharing
11 NEWS: Ombudsman sees 11% increase in education-related complaints; Restoration of Historic Quarter Master House at GC
12 The Lír Academy launches courses for young performers
13 Part-time programmes to jumpstart your career in financial services
14 Will you help Focus Ireland reach more people?
17 SOLAS and the NAO spotlight FET and Apprenticeship opportunities for School Leavers at WorldSkills Ireland and Higher Options
18 COVER: Construction skills course building careers and futures at St Andrew's Resource Centre
20 INTERVIEW: A referee for a free press. Susan McKay, Press Ombudsman
24 BRIEFING: How are students?
27 Scotland's enterprise college
28 3D printing in education from 123-3D.ie
30 Quality and Qualifications Ireland and Qualifax
33 Coláiste Dhúlaigh College of Further Education - Now Enrolling
34 Folens Active Maths 1 and Junior Cycle
37 How the right technology can save schools over €60,000
38 Footee - epic outdoor activities
40 Logistics Associate Apprenticeship - a career in getting things moving
42 Transport Operations and Commercial Driving Apprenticeship
44 Jones Engineering - Graduate and Apprenticeship Programmes
46 Samhlaigh thú féin ag Bord Oideachais agus Oiliúna Mhaigh Eo, Shligigh agus Liatroma: Bealach do Leasa
48 Longford Westmeath ETB College of Further Education
50 Energise your future with an ESB Networks’ Electrical Apprenticeship
52
Zero Latency - action packed virtual reality experience
54 FEATURE: Northern Divisions: sorting 11-yearolds. A psychological perspective on academic selection in Northern Ireland
58 Fully funded diploma in Sustainable Transport Engineering at the Bicycle Engineering Academy
60 Paving the way for your future at Crumlin College of Further Education
62 Attractive alternatives to the CAO at Blackrock FEI
64 Sallynoggin College expanding its course offering from September 2024
66 BRIEFING: The HEAR route to third level learning
68 OPINION: How to think B!G! by Kim Mackenzie Doyle, founder and CEO of the The Big Idea
71 Your future via Rathmines College
72 BRIEFING: The DARE route to third level access
74 A golden moment for PLC provision with Laois Offaly ETB
76 Irish Defence Forces General Service
81 Galway City Museum, where learning is fun!
83 GREEN NEWS: Plumbers to get €500 to pay for heat pump training; Wind farms provided 34 per cent of Ireland’s electricity in the first half of 2024
84 BRIEFING: The education system in numbers
86 LISTINGS:
86 Careers Information
87 Government Departments
87 Government Services
88 Education Institutes in Ireland
89 Education & Training Boards
89 Education Centres
90 REFERENCE: Calendars for 2024 and 2025 and school holidays for 2024/2025
40 SCHOOLS across five counties have been shortlisted for an energy retrofit programme as part of an €81 million EU funding package.
It is part of funding of €240 million for Ireland under REPowerEU, the EU’s plan to rapidly reduce dependence on Russian fossil fuels, boost security of the Union’s energy supply and accelerate the green transition.
A pool of 40 schools across five counties (Kildare, Meath, Offaly, Wicklow and Wexford) have been included in the initial assessment phase. Schools ultimately selected for inclusion in the programme will be given a deep retrofit to achieve a BER of at least B by installing heatpumps, LED lighting and mechanical heat recovery ventilation.
The fabric and airtightness of the schools will also be upgraded and electric car chargers will be installed.
SOME of the hidden costs of education for families in Ireland, from digital devices to PE kits have been revealed in a survey of 1,202 parents and guardians of primary and secondary school children by the Competition and Consumer Protection Commission (CCPC).
84% of parents are requested to pay financial contributions to their children’s schools - this excludes standard fees in fee paying schools. The average value of the contribution requested is €167 (€211 in secondary schools and €129 in primary). One-in-six parents are only informed of a payment contribution requirement after their child has started school.
Parents spend an average of €169 on uniforms and €99 on specific PE items. Parents are broadly supportive of children wearing uniforms (84%), but 40% still disagree that they can “afford the cost of uniforms without much difficulty”.
One in four parents say their child is required to purchase a laptop or tablet for
their schoolwork. This rises to one in three for secondary schools. The average cost of a laptop or tablet to parents is €501 (rising to €562 for secondary schools). 1-in-10 say they spent over €900 on a full bundle.
One-in-eight parents only found out about the payment requirement after their child had started school. Over one third of those required to purchase a laptop or tablet are buying it on credit (credit card 33%, Buy now, pay later, 5%).
The CCPC says that there are clear steps schools can take to lessen costs and make it easier for families to manage their money.
Be upfront and transparent about voluntary contributions, letting families know as early as possible how much is being asked for and what it will be used for. Schools should make it clear that the contribution is not mandatory, the CCPC say.
If parents feel their rights have been infringed, they can contact the CCPC helpline for consumer queries on 01 402 5555 or by email at ask@ccpc.ie.

THE Government has launched the ‘Bí Cineálta procedures to prevent and address bullying behaviour for primary, postprimary and special schools'.
These ‘Bí Cineálta’ (‘Be Kind’) procedures were developed in collaboration with the education partners and were informed by the views of children and young people, parents, school staff, board of management members and the wider education community.
The ‘Bí Cineálta’ procedures are centred on a child rightsbased approach and support a partnership approach where all members of the school community work together to prevent and address bullying behaviour.
The procedures have been updated to take account of gender identity bullying, cyber-

bullying, racist bullying, sexist bullying, and sexual harassment. They support schools to develop clear strategies to prevent and address these bullying behaviours.
The new procedures include getting the entire school community – students, parents, teachers, secretaries, special needs assistants, caretakers, cleaners, board of management etc – to work together to maintain a school culture where bullying behaviour is unacceptable

THERE has been an increase in the number of schools who have registered to run a Summer Programme in 2024.
More than 1,700 individual expressions of interest have been received from schools seeking to run this year’s Summer Programme – representing the highest-ever uptake of the Summer Programme. Over 1,400 schools participated in the programme in 2023.
Of the schools registered for the 2024 Summer Programme to date, there are:
• 1,475 primary schools – up 19 per cent on 2023
• 205 post-primary schools – up 28 per cent on 2023
•72 special schools – up 22 per cent on 2023 and 85 per cent on 2022. It is further anticipated that the increase in the number of children taking part in these schools will be even higher.
The increase continues an upward trend seen in the summer programmes over the last number of years. Over 50,000 children took part in the programme last year, compared to 13,000 in 2019.

Will you Walk or Cycle the Camino on the 29th of September to the 6th of October with CRITICAL?
Join us andwith everymile of your journey, you can help our volunteers to respond to medical emergencies in their communities.
You will receive aCRITICAL Fundraising Pack, the support ofa dedicated teamwho will be happy to help you on your fundraising journey, and a lifechanging experience.



A REPORT published in March 2024 details the findings of the Independent Review of Equity in Medical Devices and calls for urgent action around the development, testing and deployment of medical devices, including Artificial Intelligence (AI)-enabled

aim to prevent adverse impacts arising in new devices as they are developed.
One example of patient harm identified was the potential under-diagnosis of skin cancers for people with darker skin when using AI-enabled devices. This is as a result





THE Department of Education has published a series of reports, prepared by the Sealbhú research institute in DCU, which will inform the development of the new policy on Irish-medium education outside of the Gaeltacht.
These reports include a review of international literature on education through the medium of minority languages, reports on the various stages of the public consultation undertaken by the Department, and a series of resulting policy proposals.
The new policy for Irish-medium education outside of Gaeltacht areas will identify actions to achieve the following key objectives:
•providing a framework for the delivery of high-quality Irish-medium education in Gaelscoileanna and Gaelcholáistí and in Irish-medium early learning and care settings (for example, naíonraí) outside of the Gaeltacht;
•increasing the proportion of children and young people attending Irish-medium schools, including by building on the foundations laid in Irish-medium early learning
and care settings (for example, naíonraí);
•exploring how opportunities for the establishment of Gaelscoileanna and Gaelcholáistí can be increased as part of the patronage process;
•developing a clear policy on the establishment and sustainability of Aonaid/ Sruthanna (Irish-medium units/streams) in existing English-medium post-primary schools to strengthen Irish-medium education provision;
•examining how the supply of teachers and other staff with a high standard of Irish can be increased to meet demand in Irishmedium education settings;
•looking at ways to deepen community engagement around Irish-medium schools and early learning and care settings;
The Sealbhú research centre was commissioned by the Department to carry out a review of literature on Irish-medium and minority language education. The first report in this series contains the researchers’ findings in relation to effective practice in ten different jurisdictions where education is provided through minority languages.

AvCon, has announced the launch of "The Future of Aviation" event, scheduled to take place on November 7th, 2024, at Casement Aerodrome, Baldonnel, Co. Dublin.
The event aims to showcase the dynamic world of aviation and its myriad career opportunities to over 6,000 students from primary to tertiary education levels, with a special focus on Transition Year students.
The event has the collaboration of TYHub.ie, The Irish Air Corps, and support from aviation entities in Ireland and abroad. For more information and to register, visit www.avcon.ie.





THE County Museum, Dundalk is one of the country’s greatest secrets. Housing a collection of over 80,000 items every aspect of growing up in Louth is lovingly presented over three galleries of permanent exhibition.
Here, all of Irish history is on display be it the arrival of the first hunter-gatherers or the effects of the Industrial Revolution; the significance of the Vikings, the impact of the industrial, cultural and social expansion of the railways; the legacy of St. Brigid or the influence of the county’s diaspora throughout the world.
No aspect of the Irish story is overlooked. Artefacts on view include a three-wheeled Heinkel motorcar, King William of Orange’s leather jacket from the Battle of the Boyne; Oliver Cromwell’s shaving mirror as well as the first ever Olympic medal won by an Irishwoman (Beatrice HillLowe).

with a bespoke learning experience tailored to their specific needs.
Every item in the collection has a story behind it, one which reveals so much about the item’s owner; not only about the how and why it was used but also the nature of the society at that time.


With guided tours of the galleries and Dundalk available, a handling collection as well as an intimate 72-seater AV Theatre the Museum is uniquely positioned to provide visitors of all ages and abilities (class groups, CBA students and teachers)
A bespoke learning experience tailored to their specific needs
The County Museum, Dundalk is one of the country’s greatest secrets but sometimes a secret is worth sharing.

DUNDALK MUSEUM / 1/2 PAGE / JUNE 2023.qxp_Layout 1 30/06/2023 13:02 Page 1
More information can be had by contacting us at 042 9392999.






























JUMP ZONE IS IRELAND'S FIRST AND EUROPE'S LARGEST INDOOR FULLY INSURED ACTIVITY PARKS








Why not check out our Jump Zone Trampoline and Inflatable Adventure Parks? Our Jump Zone Sandyford Park has had a major renovation while Jump Zone Liffey Valley is conveniently located in the shopping centre, or try out our brand new Inflatable Adventure Park in Santry. We have something for everyone!!




NEARLY 4,500 complaints about public services were made to the Office of the Ombudsman in 2023. Ombudsman, Ger Deering, has seen a 30% rise in the number of complaints to his Office in recent years, from 3,418 in 2020 to 4,465 last year.
217 complaints were received in relation to public bodies in the education sector in 2023. This is an increase from 195 in 2022 (up 11%). The sector includes complaints about the Department of Education (24), and the Department of Further and Higher Education, Research, Innovation and Science.
The office received 34 complaints about Student Universal Support Ireland (SUSI), which is an increase from 23 in 2022 (up 48%). The Ombudsman said that the SUSI administration process generally works quite well but there remains no provision in primary legislation to correct errors, such as overpayments to students, where there is no fault on the part of the student.
Complaints to the Ombudsman about the administration of the Higher Education Access Route (HEAR) and Disability Access Route to Education (DARE) schemes remained the same at 21 for 2023. There were 17 complaints about Technological University Dublin in 2023, an increase from 8 in 2022. There were 12 complaints about the State Examinations Commission in 2023, 33% less than in 2022.
Chapter 4 of the Ombudsman’s annual report also summarises some of the complaints he upheld in 2023 including where a student was refused access to education scheme as ‘absent’ father had ineligible occupation
The Ombudsman considered the decision unfair and upheld Sarah’s complaint. The ‘socio-economic group’ indicator is in the process of being phased-out as one of the eligibility criteria for the HEAR Scheme.
GRIFFITH College has restored its historic gate house as part of its anniversary celebrations GC50.
Built circa 1890, the Quarter Master House is a detached three-bay, two-storey red brick building, most likely constructed following the conversion of the old Richmond Bridewell into Wellington Barracks.
Over the last year, the college has undertaken significant sustainability and restoration efforts on this iconic structure, bringing it back to its original splendour. The work of the conservation team has been overseen by Conservation Architect Gareth O’Callaghan from JCA Architects.

These extensive renovation works, meticulously carried out to the original designs, reflect what Griffith’s say is its commitment to preserving the historical integrity of its Dublin campus. The college has further ambitions to repurpose the Quarter Master House.

EVER considered a career in financial services? From banking to fintech and investment funds, it’s a dynamic sector with so much to offer. For those looking to begin a career in the sector, there are great education opportunities to help you get started. IOB is a recognised college of UCD and a leader in financial services education. With over 33,200 members working across financial services, IOB supports professionals at all career stages in the industry. Two IOB education programmes in financial advice are open to those who have completed Leaving Certificate exams.
The Professional Certificate in Financial Advice and Professional Diploma in Financial Advice are both part-time programmes accredited at Level 7 on the National Framework


of Qualifications (NFQ).
Caitriona McCarthy, Head of Financial Advice at IOB, believes that the programmes are an ideal starting point in financial services education, she says “by undertaking these courses, students can benefit from industry-recognised designations.”
The Professional Certificate in Financial Advice includes two modules: Regulation and one additional module to choose from loans, investment, life assurance and pensions. On successful completion of these modules, you will earn the Accredited Product Advisor (APA) designation in your chosen product category.
The Professional Diploma in Financial Advice is a more comprehensive programme, including six modules: Regulation, loans, investment, life assurance, pensions and financial planning.
Upon completing all six modules, you will earn a Qualified Financial





With over 33,200 members working across financial services, IOB supports professionals at all career stages in the industry
Advisor (QFA) designation, qualifying you to advise on housing loans, savings and investments, consumer credit, pensions and life assurance products.
Caitriona says “these programmes provide the knowledge and skills to build a strong foundation and excel in the financial services industry, setting you up for a successful and rewarding career.”
Take the next step in your learning journey with IOB
If you are ready to jumpstart an exciting career in financial services, IOB is here to help. For more information on these programmes or other accredited courses, visit www. iob.ie or contact us at education@iob. ie.
You can also visit us at the Higher Options Exhibition in September and learn more about how IOB can help you to achieve your career goals.







DID you know that Ireland has one of the highest and fastest growing levels of homelessness in Europe?
Even with the government’s housing plan, homelessness has increased by nearly 69% since 2018, which means for every person who left homelessness, three new people become homeless.
With almost 2,000 families and over 4,000 children experiencing homelessness, Focus Ireland needs your school’s help to reach more people and provide the support they need.
What can my school do?
Help Focus Ireland reach more people by hosting you own fundraising event or participating in one of our many challenges and events this year.
We have multiple fundraising events in the coming months; from abseiling the iconic Croke Park (over
18’s), to achieving health and fitness goals with our On The Move campaign and other bucket-list sporting challenges.
For some schools, fundraisers like bake sales, talent shows, crazy-hair days and non-uniform day are a great way to raise awareness and promote a sense of social responsibility among their students.
It also allows Focus Ireland to provide people with a secure home, tailored case management and counselling, and education, training and employment programs.
Last year, through the support of schools just like yours, Focus Ireland supported over 4,000 children across our services. And you don’t need to raise thousands to make a real difference. Every little bit of support is so valuable for our customers. Raising just €125 could help provide one week of training and educational support for a young person.

"Last year, through the support of schools just like yours, Focus Ireland supported over 4,000 children across our services. And you don’t need to raise thousands to make a real difference
Sleep out against Homelessness this October
Make a powerful statement of solidarity for one night and sleep out against homelessness.
Join Focus Ireland, proudly supported by Bord Gáis Energy, for Shine a Light on October 11, 2024 and help raise vital funds to help children and families who are experiencing or are on the brink of homelessness.
Organising a school sleep out is easier than you think. All you need to do is gather interest in your school community, commit to a fundraising target, and organise the night. Our dedicated Community Fundraising Team can provide you with any support and items you may need like fundraising buckets, posters and sponsorship cards.
If you have any questions or would like more information, feel free to contact our team at events@focusireland.ie.












AS THE world evolves everything in it must evolve too - or inevitably gets left behind. Plants, animals, people, technology – even education is ever evolving. Not so long ago, degrees could only be earned from within the confines of a classroom, nowadays we can study from anywhere, at home, in a café, abroad. However, there is one area of life that remains steadfast and not so changeable and that is good old fashioned - very traditional - earning a living. So traditional in fact we’ve coined it with phrases like ‘bringing home the bacon’, ‘putting bread and butter on the table,’ ‘earning a crust.’
Unfortunately, traditional education curriculums mean students having to rote learn, memorizing text off by heart for exam purposes rather than digesting information as a way of understanding and utilizing it which can cause real disconnect with the world.
Transition Year affords students space to learn, mature and develop without the looming pressure of exams. For students it’s a transition on many different levels, from childhood to adulthood, dependent to independent, school life to work life etc.
And when it comes to getting that first summer job, understanding their payslip will benefit them well into the future when entering the employment market.
Priceless!
1. The Word on Financial Speak
Like any subject, finance has its own lingo too and needs to be broken down (into bite size chunks) and simplified so it can be easily digested. Learning and understanding terms like Personal Taxation will help students now and in later life make better decisions, have better control over their financial affairs when it
comes to earnings, important life events and applying for a mortgage etc. Knowledge being key.
2. Going Pro
The modern-day job market demands that, every employee and entrepreneur eats, sleeps and breathes, Personal Taxation - otherwise they’ve no business being in the business game.
Teaching students about Tax Credits and Deductions will give them a good head start financially in both their personal and professional lives. Going to college is a particular time in their lives when they need to be looking at inventive ways to save money. So, learning that there is a tax credit available for qualifying college fees, can help save on tax and is valuable information to have.
3. Rainy Days & Sun Holidays:
Learning to budget from any age is a lifelong skill, teaching students simple financial planning tips and tricks can lead to being better prepared for the ups and downs of adult life. Whether it’s saving for that trip of a lifetime or having to splash out on a new car because the old one is banjaxed. More importantly learning to budget reduces financial stress and helps students to adopt financial accountability, e.g. assigning wallet apps for savings, utilities, music, clothes etc.
By showing students, what the breakdown on the payslip means regarding take home pay and how to have control over their earnings they are equipped with skills they can put into practice in real life situations.
4. Health Really is Your Wealth
We are our own currency and if we don’t put value on our self then who else will. Our sons, daughters – students - deserve the best start in life and if we’re sending them out into the world then we do best by them,
Transition Year affords students space to learn, mature and develop without the looming pressure of exams.
by equipping them with skills we know they’ll need to survive and thrive.
Earning a living is a major one, which takes up most our waking lives. So, it’s only fitting that we put value on our time and how much we get paid for that time. Personal taxation education is an investment in preparing students for the realities of the professional world.
Digital media offers a wealth of bitesized learning where even the most comprehensive subjects are simplified and digested via explainer animations and apps.
Learning to budget reduces financial stress and helps students to adopt financial accountability, e.g. assigning wallet apps for savings, utilities, music, clothes etc
Online platforms now provide easy access - banking apps on our phones can provide breakdowns of where we are spending money providing insights for cost cutting and areas to save. Sites like Citizens Advice simplify complex information into easy-to-understand language and these are readily available at our fingertips.
The working road is a long one from students leaving school until we are lucky enough to retire. However, the balance is tipping – most notably the introduction of the four-day working week for better life/work balance, so we have adopted this in our workplace.
Learning to look after our financial health benefits our long term wealth – that’s the bottom line.
Lesa Malone is a Business Finance Partner at Brady Management Global, Financial Consultant and Mentor and Trainer with a special interest in Transition Year financial tutoring.
For more information on Lesa’s Introduction to Finances course covering many areas (setting up Revenue Account, Emergency Tax, First Pay Slip, Tax Credits, Tax Relief, Deductions, PRSI, Income Tax etc) please reach out at www.bradymgt.com and get in touch.

FURTHER Education and Training (FET) and Apprenticeships offer Leaving Certificate students a wealth of smart options to unlock their potential after school. Providing valuable and recognised post-secondary learning pathways outside of the points system to school leavers, FET and Apprenticeships offer a broad variety of choices that are wellpositioned to lead them on to a world of exciting careers.
The extensive range of opportunities available to school leavers through FET courses at QQI levels 5 & 6 and Apprenticeship programmes will be showcased at both the World Skills Ireland and Higher Options exhibitions over three days in the RDS, from Wednesday, 25th September until Friday, 27th September at the RDS, Dublin.
SOLAS, the further education and training authority, together with key partners from the National Apprenticeship Office (NAO) and the Education and Training Board (ETB) network, will have a strong presence at both events, highlighting endless opportunities for school leavers to leave the points race behind and shape their own pathway towards a future career that suits them through FET and Apprenticeships.
Attendees can find information at numerous stands throughout both events where they can discuss the many options across FET including over 2,000 Level 5 and 6 PostLeaving Cert courses available at local level in every county, and 75 Apprenticeship programmes on offer across a wide variety of cutting-edge, dynamic industries.
See skills in action at WorldSkills Ireland 2024
For those interested in exploring skillsbased careers with Apprenticeships, WorldSkills Ireland brings enterprise, industry, education and training together showcasing Ireland’s future skills careers and
leading skills makers in one room.
Discover a world of exciting Apprenticeships, from traditional craft programmes like Stonemasonry, to recently developed programmes in hairdressing and cybersecurity, through interactive displays, run by ETB networks across the country, as well as information on all 75 Apprenticeship programmes at the NAO’s Generation Apprenticeship Hub.
Visitors can get inspired at ‘The Heroes Stage’, witness inspiring career journeys of Ireland’s ‘Apprentice of the Year’ nominees, and find essential career information at the Educators’ Zone. Students can also ‘try-a-skill’ for themselves, watching exciting skills competitions unfold over two days, as Ireland’s top skills makers battle to win national titles to compete at WorldSkills events internationally, in cheffing, carpentry, mechanics, hairdressing and more.
What’s in store at Higher Options 2024?
SOLAS and the National Apprenticeship Office will continue their partnership with the Higher Options event in 2024, where students can find essential information on a multitude of study, training and career pathways to help them make informed decisions on post-leaving certificate options.
In addition to higher education and international exhibitors, students, guidance counsellors, and teachers will have a great opportunity to speak directly with representatives from a selection of Education and Training Boards and FET colleges from locations across the country, together with the National Apprenticeship Office’s Generation Apprenticeship team, to gain essential information on local opportunities for school leavers across FET and apprenticeship provision.
FET and Apprenticeships will be an important feature in a number of careers talks

Students can explore a world of skills and career talks across FET and Apprenticeships at World Skills Ireland and meet Apprentice of the Year 2024 nominees on ‘The Heroes Stage’
scheduled to take place over three days, ensuring that students have the opportunity to consider all pathways and opportunities before taking their next steps after school.
The National Tertiary Office will also be available to highlight the 40-plus joint degree programmes now on offer across the country. Through these programmes, students commence a degree programme in a Further Education and Training College. They spend 1-2 years there and then automatically transfer (subject to passing exams) to a higher education institute to complete a degree programme.
This September, make sure you and your students explore the broad range of FET and Apprenticeship programmes on offer nationwide at WorldSkills Ireland and Higher Options. Please note that booking in advance for each event is essential for entry on the day.
Find out more about opportunities through FET for school leavers at thisisfet. ie or explore the diverse range of 75 Apprenticeships at apprenticeship.ie.




By CONOR MURPHY
IT’S A Thursday afternoon at the Construction Skills Course at Dublin Port. For Jim Hargis, Education and Training Hub Manager for St Andrew’s Resource Centre, it’s just another induction day.
However, for the roughly 30 people in the room who are the latest programme hopefuls, what he is saying could be truly life changing.
“I don’t know anything about construction work and I’m not an official of any sort,” Hargis tells the room with a wry smile.
“But I do know about employment and jobs. What I can promise you is this course will take away all the barriers in front of you when it comes to giving you what you need to find a job. This course is not about catching anybody out and nobody fails. We don’t care about your past, we don’t care about your CV. Whatever you need to find a job, we will support you in any way we can.”
Hargis has been working on the Construction Skills Course since its inception in 2017. The origins of the
programme can be traced to a joint effort involving the Department of Social Protection, St Andrew’s Resource Centre, and Dublin City Council.
The endeavour emerged from the necessity for a nearby workforce to aid in the construction of the incinerator site in Ringsend in 2016 and the Strategic Development Zones in Dublin Docklands. St Andrew’s Resource Centre formulated a plan to streamline the hiring process for local workers on the eastern side of the inner city.
The programme’s core philosophy is evident: to deliver unemployed individuals with the necessary tools for success in the construction sector. From supplying Personal Protective Equipment (PPE) to instilling essential skills and promoting a strong work ethic, the curriculum strives to ready individuals for the challenges of construction labour.
The results from this one-of-a-kind course speak for themselves with over 65% of graduates gaining a job
"If an employer asks us on a Thursday for a change on the modules, we can have that in place by the Monday and that gives us a real advantage.
“We are redefining relevant upskilling in a unique environment to meet employers demands.”
start after completing the three-week programme. Notable companies that have hired graduates include John Sisk & Son, Careys Building & Civil Engineering, Walls Construction, Alufix, and Clarke Concrete.
“Back when we started this in 2017, we thought we’d run eight courses and graduate 50 people. We thought that would have been a good result. It’s hard to believe how far we’ve come,” Hargis said.
Fast forward seven years and the course has now seen 1,300 graduates.
Alec Hayden, who owns and runs Construction Industry Training which provides training for the course, believes there are several reasons for the success of the programme.
“What we do is deliver a hands-on, practical course that is managed in house and meets the needs of employers,” Hayden explains.
“For example, if an employer asks us on a Thursday for a change on the modules, we can have that in place by the Monday and that gives us a real advantage.
“We are redefining relevant upskilling in a unique environment to meet





employers demands.”
Hayden admits he “lives and breathes” the course and is constantly amazed by the people he meets through it.
“Some of the stories and the people we come across, it’s incredible,” Hayden said. “We had one person, an asylum seeker, who saved up their money each week to top-up their Leap Card so that they could get here and back each day from Galway on the bus. There are countless stories of people who have used this course as a springboard to turn their lives around.”
Hargis and Hayden have seen the type of candidates they are attracting diversify in recent years as word of the course has grown. As well as Dubliners, today there are both male and female from over 40 nationalities and all types of backgrounds.
Patience Dube worked in an administrative capacity in a secondary school in her native Zimbabwe. After completing the programme last summer, and also adding a cleaning
"I went into the course thinking ‘this might not be for me’ but I had mates who worked in construction, and they said go for it – it really worked in my favour"
course to bolster her skillset, she was hired to work within the programme.
“Patience understood exactly what we were about from the moment she set foot in the door,” Hayden explained. “Her work ethic and the way she carries herself stood out to us. As luck had it, we needed someone to work in an admin role and we always believe it’s best to upskill those familiar with the programme.”
“I learnt so much from the course,” Dube said. “They helped me with my application for a work permit and promised me a job while I waited for it to be approved. They checked in with me every week and it meant the world the me that they waited.”
Michael Ryan is a 27-year-old graduate with a very different story. Having spent six months in Mountjoy Prison, he emerged seeking to turn his life around. Ryan points to the support he received during three weeks on the course – and beyond – for doing just that.
“If it wasn’t for the lads running this course I wouldn’t be where I am today,” he admitted. “I am a laidback person by nature, but I focussed my


mind for this course when I got out of prison. It helped me turn my life around. I went into the course thinking ‘this might not be for me’ but I had mates who worked in construction, and they said go for it – it really worked in my favour.
“Even after I had completed the course, Alec and the team helped me prep for the job interview – they couldn’t have done enough for me. I got the job coming out of the course in 2022 and I was made permanent about a year later, just before Christmas. My life is back on track. I have a girlfriend of six years, I have a kid on the way and I’m now saving for a house. I know for a fact none of that would have been possible if I hadn’t done the course.”
The course – which runs throughout the year - continues to go from strength to strength and expects to cross 2,000 total graduates in 2024.
For more information, email: Jim.hargis@standrews.ie or call 083 166 4892
Susan McKay was appointed Press Ombudsman in 2022 at a time of enormous change for the traditional press. Niall Gormley spoke to her about role.
SUSAN McKay is well known in journalist and writing circles for her reporting and commentary in Ireland over the past 30 years.
Born in Derry, she studied at Trinity College in Dublin and at Queens in Belfast. Her degree in Trinity covered English language and literature as well as French language and literature. In 1990 she completed a Master's in Journalism at Dublin City University.
Her journalism has always been mixed with activism, sometimes outside of the press. She has been vocal on children's and women's rights and her first book was Sophia's Story, about a child abuse survivor.
Inevitably, for someone raised at the beginning of the Troubles in the North, she has also written extensively about Northern affairs and has penned two books on the changes in the Protestant community as the Troubles and the peace process progressed.
The first book, Northern Protestants – An Unsettled People , comprised a series of interviews with people all over Northern Ireland published in 2000. A groundbreaking book, not least because of McKay's own Protestant background, it involved closely observed interviews together with commentary and context.
The second book published in
2020, Northern Protestants: On Shifting Ground, updates the first and feeds into the broader discussion about Northern Ireland in the wake of Brexit and talk of a border poll and a United Ireland.
McKay has also used both radio and television in her work and has produced documentaries in both mediums.
In October 2022 she was appointed Press Ombudsman at a time when the traditional press is under severe pressure. A perfect storm of online content and online advertising has robbed newspapers and magazines of both readers and revenue.
Radio has performed better and arguably has added the popular world of podcasting to its stable.
Traditional TV has also suffered as viewers have moved to streaming services.
The Press Council was set up to see off the threat of government regulation and the costs of legal actions, which can sometimes exact ruinous costs on publishing companies. Issues around privacy and accuracy were increasing the pressure on the state to act, and the scandals in the UK over phone hacking were not helping.
bound to observe. Part of the idea is to have an arbitrator to decide on complaints based on the code and the office of the Press Ombudsman is that referee.
The rationale
So what does Susan see as the rationale behind the Press Council?
"It was set up at a time when it looked as if the government was contemplating statutory regulation for the press, and the press did not want that, for obvious reasons. So that was why they decided that they would put forward their own proposal for a self-regulatory scheme. And that scheme was then noted in the defamation law - noted that the Press Council exists."
The reason that this is important to the press is that it helps directs complaints away from the courts. People who believe that they have been wronged can go through a process while still reserving their right to go to law later.
The standard that the Press Ombudsman measures to is the Press Council Code of Conduct which commits Press Council members to certain standards in how they carry out their journalism. It also commits them to the process.
Susan says that therefore the press members take the process seriously because they have to abide by the Facebook, Twitter, Instagram. None of those platforms are answerable to us in any way in their own right. And that’s the problem. They they publish stuff and they republish stuff. And they have no editorial standards
So the Press Council was born and has developed a Code of Practice which its members and writers are
decisions that she makes.
"So the system that we have in Ireland is that the ombudsperson is the person who interprets the code, and then the Press Council’s job is to ensure that I have done it according to all the proper procedures and that I’ve applied the code correctly.
"So if a person isn’t satisfied with my decision, they can appeal, but they have to appeal on certain grounds. Primarily the press industry has vested in me the authority to interpret the code. "
Online is different
I ask her about the problem of regulating the online space, which seems to be a Wild West when it comes to the idea of libel. Simply put, Irish defamation law doesn't extend to the online world. What about Twitter, as we used to call it?
"If it’s the official Twitter platform of a publication, yes. So if, say, a newspaper operates a Twitter account and they publish something on Twitter, there could be a complaint made about it. But in general, we don’t cover the social media platforms.
"And what you often find is that they are where all the hatred gets generated, because people who write in the newspapers are 'legalled', lawyers would do their best to ensure that nothing is published which could be a in breach of the code of principles of the Press Council.
"If something is published by a publication on their official social media accounts, then we can take complaints about those.
"We can only oblige them to agree not to publish something like that. But Facebook, Twitter, Instagram. None of those platforms are answerable to us in any way in their own right. And that’s the problem. They they publish stuff and they republish stuff. And they have no editorial standards."
Ms McKay says that the nature of complaints have changed over the years. The first ombudsman was John Horgan and he dealt mainly with queries around truth and accuracy, which is covered by Principle 1 of the code.
The second ombudsman was Peter Feeney and he was in charge during the Covid outbreak. Many of the complaints he received was around press impartiality and there were
'A fundamental principle of press freedom is that people have to respect the right of journalists to go about their business
"Most sensible people get off side when there’s a riot happening. Journalists have to stick around"


orchestrated campaigns around the efficacy of the Covid vaccines. Because many of the complaints were similar the Office devised a method of allocating a 'lead complaint' to be adjudicated upon.
"A lot of what I seem to be doing is dealing with complaints about identity. Issues to do with LGBT rights," she says.
Specifically the trans issue, which is a feature of the culture wars online and both sides of the Atlantic, seems to rile a lot of people.
"Obviously, you know, where there are there are people who are challenging the right of trans people to assert rights at all. Whereas obviously the code of practice expressly recognises that under Principle Eight.
"It says the press shall not publish material intended or likely to cause grave offence or stir up hatred against an individual or group on the basis of race, religion, nationality, colour, ethnic origin, membership of the travelling community, gender, sexual orientation, marital status, disability, illness or age. I take this to run right through the entirety of the code, that those groups of people enjoy that protection."
Many complaints that the office receives now are around the protests against migrant accommodation. Some people object to being described as 'far right' or 'racist'. Other complaints are about local communities being associated with the protests. She says that her office can't deal with these issues because the people complaining are not identified in articles and are not personally affected by them.
The national press has been running a vociferous campaign to have the defamation laws changed. Their stance is that there's too much risk involved in leaving it up to juries to decide the level of awards and some cases in the past 20 years have cost seven figures in awards. One idea is to let the jury decide on guilt or innocence and allow the judge to set the award. Another idea is to abolish juries altogether.
There is a promise of a defamation law in the Programme for Government but it is looking increasingly likely that it won't be passed before the rapidly approaching next election. She agrees that time is running out for the legislation to pass.
"Obviously our members are extremely anxious that it should go through because at the moment they are at high risk. And it’s not just how
much might be awarded against you.
"It’s also because the cost of the preliminary defence is expensive. Like you’re going to have to get your lawyers involved at a very early stage. And so papers can be out a huge amount of money without a case ever even making it to court.
"And then, of course, when it does get to court, the cost of proceedings is extremely high. There’s the risk of an enormous judgement against you and at a time when our members are suffering serious loss of income, not least because of social media dominance."
She says that these costs can be enough to potentially close a newspaper or lose a couple of journalists because they can no longer afford to pay their salaries. It means that a paper might have to curtail coverage due to a lack of resources.
The problem of Slapps
If the issue of common-or-garden defamation wasn't enough for the press to deal with, there's also the strategic use of the law to threaten reporters.
Strategic Lawsuits Against Public Participation or SLAPPS are now acknowledged internationally as a means of the powerful and wealthy to intimidate news organisations.
In 2023 then taoiseach Leo Varadkhar in the Dáil accused Sinn Féin of using lawsuits against the media: "to shout them down or sue them". This is a position that Sinn Féin denies and while there have been numerous court cases involving party members, the party has also been targeted particularly in its relationship to the IRA during the Troubles.
Ms McKay recognises that SLAPPs are a reality for the press.
"It’s recognised in that term that they are they are designed to stop newspapers from doing what newspapers should at their best do, which is investigate power and explore abuses of power. So they are they are designed to stop people doing investigative work and they are very obviously then a contradiction of the notion of freedom of the press."
I ask her does she think that people should see the ombudsman as an alternative to going to court?
"We are very much advocating for that. And it’s interesting to see that recently a number of senior judges have talked about the importance of alternative dispute resolution, which the Press Council offers through the Press Ombudsman’s Office," she says.
It’s also because the cost of the preliminary defence is expensive. Like you’re going to have to get your lawyers involved at a very early stage. And so papers can be out a huge amount of money without a case ever even making it to court.
She also points out that the service is free and is much quicker than the legal route.
"The whole process here could be done within three to five months. Which is nothing compared with a court case. In fact, it could be quicker than that."
People wishing to object to something printed have to act within three months of the article being published. Ms McKay will ask them to lodge a complaint with the publication first to see if that can resolve the issue. The office will work with the two parties through responses and reply. These typically take 10 days each.
If it ends up that the Ombudsman has to make an adjudication then the decision takes three to four weeks.
"Then that’s either the end of it, or one or other party appeals it to the Press Council, and they will usually hear it at the nearest next monthly board meeting," she says.
Defending the journalist
I think it’s really good for girls to have role models, and I think it is good to have a woman in this role
Susan is particularly vehement in her criticism of violence and the threat of violence against reporters.
"I always at every opportunity say that there is there can be no freedom of the press where there’s intimidation of journalists or violence against journalists. A fundamental principle of press freedom is that people have to respect the right of journalists to go about their business.
"It’s in the nature of journalism that you have to put yourself into very tricky situations, to say the least. Most sensible people get off side when there’s a riot happening. Journalists have to stick around.
It’s interesting to see that recently a number of senior judges have talked about the importance of alternative dispute resolution, which the Press Council offers through the Press Ombudsman’s Office
"Most people would get out of the way if there was shooting. You just have to observe it. Most people, if there’s a car crash, will go on the other direction so as not to see upsetting things. Journalists have to get in there. Journalists are always working in circumstances where there’s violence."
What's in a name?
Of her own role she says: "I think it’s really good for girls to have role models, and I think it is good to have a woman in this role."
Susan doesn't accept that the word 'ombudsman' is gender neutral. The idea that 'man' is just a gender neutral word for 'human' is illogical and she doesn't accept it for a minute.
The name is still on the website and the issue is up in the air. It won't be up in the air, you suspect, when Susan McKay's term is up.



CIVILS
FIBRE INSTALLATION TECHNICIAN
OVERHEAD LINES OPERATIVE
SCUBA DIVING INSTRUCTOR


NATURE BASED EARLY LEARNING AND CARE
EMERGENCY CARE STUDIES (EMT TRAINING)
CONTENT DEVELOPMENT FOR FILM AND TV














survey asked the degree to which students agreed with several statements about experiences in higher education. Figure 3.1 presents responses to the statement “It was I would study in higher education” across key characteristics.

A feeling of ‘belonging’ with higher education could be seen as a consequence of feeling comfortable within your study programme and being able to share your experiences with other students, so that individual students do not feel isolated from their classmates. This appears to be supported by the results shown in Figure 3.3. Respondents in this chart were asked the degree they agreed with the statement “I often have the feeling I do not really belong in higher education”. As is shown in this chart, at the aggregate level 61 percent of students disagree or strongly disagree with this statement. The pattern is largely uniform across the key characteristics though there are higher levels of disagreement for postgraduate students and part-time students.
Figure3.10presentsasimilarpictureinthatmorestudentsfeelthattheirchancesofgettinga job in the international labour market are good or very good than poor or very poor. At the aggregate level 60 percent of students feel that their chances are good or very good. The highest levels of 71 are for Health and Medicine, Dental Studies students. Furthermore, the percentage of students who feel that they have a poor chance of obtaining a job in the international labour marketis still relatively low at only 13 percent of the total student population. However,this rises to 22 percent for Arts and 23 percent for Humanities students. What is striking in these charts is that for a large proportion of Arts and Humanities students feel that their chances of getting a job are poor in both the national and international labour markets.
Table 5.1: Who do you live with during term-time (Monday to Friday)? [N=14,939]
Parents/ guardians (or grandparents, uncles, aunts, or similar) Partner/spouse
53 percent live with their parents and 41 percent live with other people. However, for part-time undergraduates only 19 percent live with their parents and 11 percent live with other people, instead 55 percent live with their partner or spouse, and 34 percent live with their children. What we observe here, and the trend seen at postgraduate level, could be a function of age, as noted in Chapter 1, full-time undergraduate students are younger than all other students, and part-time undergraduates tend to be older than all other groups of students. The distribution seen across age in Table 5.1 lends support to this as 58 percent of students under the age of 22 live with their parents, and this proportion decreases as age increases, and the proportion living with their partners or spouses increases as age goes up.

Table 5.1: Who
HEI Type
My child(ren)/my partner’s child(ren)
With (an)other person(s) not mentioned above (students, friends, etc.) I live alone
live with during term-time (Monday to Friday)? Continued
Parents/ guardians (or grandparents, uncles, aunts, or similar)Partner/spouse
My child(ren)/my partner’s child(ren) With (an)other person(s) not mentioned above (students, friends, etc.)I live alone
13 Lyons, R. The Daft.ie House Price Report – An analysis of recent trends in the Irish residential sales market for 2022 Q3. Lyons, R. The Daft.ie Rental Price Report – An analysis of recent trends in the Irish rental market for 2022 Q3.
Dublin-base HEI?
Who do you live with during term-time (Monday to Friday)? Would you say that because of who you are: you have experienced sexual harassment
Figure 11.4: How safe do you feel in the dark walking
[N=13,228]
Figure 11.5: How safe do you feel
We invite you to register for the wonderful world of eTwinning – an innovative online platform linking a community of more than 1 million teachers and their students across Europe.
Using information and communication technology, eTwinning supports schools to partner with other countries and work on creative projects in any curricular area of interest. You can build on projects or initiatives your students are already working on in class, discover what schools in other countries are working on and join in, or start small and simple with one of our themed, curriculum-linked project kits.
Joining and participating in the eTwinning community is a unique and hands-on way to help your students engage in:
• Cross-curricular learning
• Digital literacy
• Multicultural communication
• Language exchange opportunities
• Local and global collaboration and action
eTwinning projects often lead to further European engagement.
Plan an eTwinning project and take your first step towards an Erasmus+ project where you can:
• Teach or job shadow in a partner school
• Attend training courses abroad
• Send your pupils on short-term exchanges
Contact Léargas to find out more
etd@leargas.ie | www.leargas.ie school-education.ec.europa.eu/en/etwinning


SCOTLAND’S Rural College (SRUC) is a specialist institution offering college and university level courses, focussed on the natural economy, fuelled by the responsible use of the world’s natural resources: people, land, energy, water, animals and plants. In this, we are experts.
We focus on solving the global challenges facing the planet, including climate change, biodiversity and access to nutritious food and clean water.
By focusing on the sustainability of our natural resources, SRUC will strive to make a world of difference: delivering economic, social and environmental benefits for all, both locally across Scotland, the UK, and beyond.
Whether your passion is for business, science, food, engineering, golf, plants, animals, sustainability, the environment, or just the great outdoors, you will find courses at SRUC tailored to meet the needs of a whole range of industries.
Issues such as environmental impact and sustainability have an effect on all our lives and are of importance whether you have ambitions to manage your own business or a farm, be a scientist or a government advisor.
SRUC’s courses consider the innovative science that supports land-based and rural industries, the way they interact with and support the environment around them, and the businesses that rely on them – from agriculture and business to veterinary and zoonoses, and a huge variety of relevant topics in between.
Today, SRUC is on a journey to become Scotland’s enterprise university at the heart of our sustainable natural economy. A key part of this journey is the opening of the SRUC School of Veterinary Medicine in Aberdeen.
As only the third veterinary school in Scotland and the first in over 150 years, the SRUC School of Veterinary Medicine will use innovative teaching methods to prepare students for work in the increasingly important rural mixed practice, agricultural and food sectors.
The first students on the BVSci Veterinary Science degree will begin studies in 2024. The new curriculum not only embeds students in real-life practices but will address a number of key issues within the wider rural and veterinary sectors.


















Whether you need trusted information or confidence in qualifications ...
An updated NFQ
Irish Register of Qualifications
Quality reviews
#myownwork
QQI Award
Qualifax
... QQI has you covered.




Cibé acu faisnéis
iontaofa nó muinín as cáilíochtaí atá á iarraidh agat…
NFQ nuashonraithe







Clár Cáilíochtaí na hÉireann
Athbhreithnithe cáilíochta
#myownwork
Dámhachtain QQI
Qualifax
...bíodh iontaibh agat as QQI.























When it comes to your CAO journey, the possibilities are endless.
Qualifax helps students, parents and guidance professionals navigate the CAO process. With a database of 15 000 courses, you can:
•Find detailed information on all CAO and PLC courses – entry requirements, points history, subjects taught, career paths and further progression
•Save and compare favourite courses
•Identify CAO subject requirements
•Calculate the points you’ll need
Qualifax – every course explained
Níl teorainn ar bith leis na deiseanna atá romhat agus tú ar do thuras CAO.
Cabhraíonn Qualifax le mic léinn, le tuismitheoirí agus le
treoirchomhairleoirí a mbealach a dhéanamh trí phróiseas an CAO. Le bunachar sonraí de 15 000 cúrsa, beidh tú ábalta
•mioneolas faoi gach cúrsa CAO agus
PLC a fh áil – riachtanais iontrála, stair pointí, ábhair á múineadh, conairí gairme agus bealaí chun cinn
•na cúrsaí is fearr leat a shábháil agus comparáid a dhéanamh eatarthu
•riachtanais ábhair CAO a shainaithint
•na pointí a bheidh uait a ríomh
Qualifax – míniú ar gach cúrsa

The decisions you make right now are literally life changing – so why not think about an exciting career that won’t just change your life, but other people’s too?
Find out more about optometry career paths when you scan the QR code.




CDCFE are currently enrolling for over 70 courses that they offer across their three campuses in Coolock, Raheny and Kilbarrack.
Coláiste Dhúlaigh College of Further Education has 13 faculty departments, which offer a broad range of programmes from Animation to Science & Technology.
As well as Post Leaving Certificate courses for school leavers, CDCFE also provides qualifications at QQI levels 4, 5, & 6 as well as Apprenticeship, Work-based Traineeship programmes, BA degrees and a selection of part-time day and evening courses. Most courses charge a €50 registration fee for the year, making it an attractive option. Mature students, and anyone wanting to return to education are welcome to apply for enrollment.
Why choose Coláiste Dhúlaigh?
Students at this college get a personal learning experience from supportive tutors in a relaxed environment. Curriculums are majority continuous assessment, taking exam stress out. CDCFE has excellent progression routes to higher education through the CAO system, as well as links with University of Wolverhampton to BA degree level in the areas of Animation and TV & Film Production, which are delivered in the Coolock campus. The Erasmus+ mobility programme allows students the opportunity to study abroad with our international partners in Corsica, Spain and Italy.
PLC courses are an affordable option for students who are unsure of their future career path and would like to try out a subject area before committing to a full degree. Qualifications also provide a route into higher education for students who did not meet CAO entry requirements for university. Post Leaving Certificate courses are available in disciplines such as Media, Business & Tourism, Information Technology, Health Sciences, Social Studies & Education, Art & Design, Performing Arts and many more.
For students who want a practical
experience, CDCFE offers workbased learning through its Traineeship programmes . These courses provide a work placement with CDCFE’s industry partners. Traineeships are available in the areas of Tourism & Hospitality, Logistics & Forklift Training, Outdoor Adventure Management, Building Information Modelling and TV & Film Production.
Coláiste Dhúlaigh also offers the National Hairdressing Apprenticeship, which allows participants to earn while they learn. Apprentices work in a professional salon four days a week, and study at CDCFE’s fully equipped salon “Cabello” on one day, allowing them the chance to become qualified hairdressers. The NHA is the only fully recognised international hairdressing qualification.
CDCFE’s part time day courses are funded through the government’s
"Students at this college get a personal learning experience from supportive tutors in a relaxed environment. Curriculums are majority continuous assessment, taking exam stress out"
Back to Education Initiative (BTEI), which offers participants the chance to gain certification in areas like Early Learning & Care (ELC), Pottery, Healthcare, Barbering, ESOL, Entrepreneurship, Horticulture, Youth Activity Worker and Café & Deli Skills with Barista Training. Graduates of these programmes can progress into employment, or onto further and higher education. The Skills to Advance programme at Coláiste Dhúlaigh CFE provides government-subsidised training courses for employers who want to upskill their workforce. CDCFE can offer bespoke programmes based on employers’ needs, for example in Health & Safety, Healthcare Skills, Digital Marketing etc.
For more information about all the courses that Coláiste Dhúlaigh CFE provides, follow them on social media or see more at www.cdcfe.ie.



































Looking for a new programme for one of your Junior Cycle subjects?
We’re sure to have a solution for you. All our programmes include engaging digital resources, student eBooks and planning support to save you time. They also offer guidance to assist your students in completing their CBAs and preparing for exams.
Your local Rep can provide you with information and samples for all our programmes, as well as discounts to help meet your school needs.

Go to Folens.ie to take a closer look at the books, digital resources and planning







All the essential teaching tools, plus quality you can trust, at a price that will surprise you. SMART GX is the well-equipped, affordable option from the makers of the original SMART Board® interactive display. Backed by SMART quality, get the essential teaching tools you need and the peace of mind you deserve. Now with up to 40 points of touch.




Maximise student engagement, save teachers’ time, and simplify IT management with the durable SMART Board® MX series interactive display. Enjoy seamless cloud storage integration and powerful interoperability for Google for Education, Microsoft Office 365 apps, and all the other apps your teachers need with integrated access to Google Play Services.

Built to evolve around your needs with marketleading ease of use, the RX series is the only interactive display that offers userprogrammable tools to help you support inclusive classrooms. Next-level engagement starts here.

Scan to connect with a SMART representative today.










intuitive interface makes it easy for teachers to integrate the GX Series into their lessons, regardless of their technical expertise. Extensive connectivity options, including HDMI and USB ports, allow seamless integration with other classroom technologies.
The GX Series is not just about energy efficiency; it's about a holistic approach to sustainability. The displays are Energy Star certified, ensuring they meet stringent energy efficiency guidelines.
Additionally, the GX Series is ISO14067 and ISO14064 certified, which means they meet high standards for carbon footprint reductions. SMART has also made significant strides in reducing the environmental impact of their manufacturing and packaging processes. Globally, SMART has achieved a 75% reduction in styrofoam, 40% reduction in wood, and 10% reduction in cardboard in their packaging.
Furthermore, 100% of the final assembly test and packaging of the GX Series are done with renewable energy sources. The new GX Series is 52% more efficient than the current average interactive flat panels.
Two Irish schools have recently showcased the transformative impact of integrating SMART's interactive displays into their classrooms.
"The durable screens are resistant to scratches and damage, ensuring longevity and reliability. The intuitive interface makes it easy for teachers to integrate the GX Series into their lessons, regardless of their technical expertise"
At Listellick Primary School, the introduction of SMART technology has revolutionized the teaching and learning experience. The school's principal highlights how the energy efficiency of these displays has not only reduced electricity bills but also contributed to the school's sustainability goals.
Similarly, Caherleaheen National School has embraced the benefits of SMART's interactive displays, enhancing both teaching methods and student engagement. The staff at Caherleaheen have praised the technology for its reliability and intuitive interface, which have made integrating technology into the classroom seamless.
Join the growing number of Irish schools that are transforming their classrooms with SMART's GX Series. Experience the difference that energy-efficient, interactive technology can make in your educational environment.
For more information on the GX Series and to see how it can benefit your school, visit www.smarttech.com or call us on +44 800 029 3302 today.







ORGANISING, co-ordinating, managing, and moving goods is what logistics and supply chains are all about. They involve planning, implementing, and controlling the movement of products and information.
Logistics and supply chains are integral to every industry in the world and operate around the clock facilitating international and domestic trade in all sectors of the economy.
The industry offers a wide variety of career paths, including operational roles e.g.: picking orders in a warehouse or driving heavy goods vehicles, and management and supervisory roles primarily based in the office that involve developing and implementing logistics plans, analyses and optimisation of logistics
frameworks.
In addition to competitive salaries, logistics and supply chain careers offer opportunities for advancement, and career growth as well as opportunities for international travel.
Critical thinking and problemsolving skills are vital for anyone looking to pursue a career in this vibrant and fast-paced industry.
Earn as you learn
The ‘Earn as you learn’ Logistics Associate Apprenticeship (LAA) offers career and education options for school leavers and mature students who prefer paid, on-the-job training while studying for a qualification over a full-time college course. There are 120 companies registered with the programme that offer
"There are 120 companies registered with the programme that offer placements throughout Ireland... ...and 375 apprentices have been enrolled since the program was launched in 2018"

placements throughout Ireland, representing manufacturing, warehousing, distribution, shipping, and freight forwarding sectors and 375 apprentices have been enrolled since the program was launched in 2018.
How does the logistics apprenticeship work?
The LAA is a two-year programme providing academic education and practical on-the-job training across the logistics industries. Apprentices enter a contract of 2 years duration, where they will work on a full-time basis with an employer while being paid a salary and spend one day a week with (MTU) Munster Technological University Cork Campus or TU Dublin City campus for their academic studies.
Successful completion of the apprenticeship will lead to a QQI Level 6 Award on the NFQ - Higher Certificate in Logistics.
From that point, there are many routes of progression into Level 7 and even Level 8-degree courses which is one of many key strengths of this programme. Throughout the apprenticeship journey, apprentices acquire the knowledge, skills, and competencies to carry out the core tasks and responsibilities within the logistics sector and upon completion of the program are fully equipped to progress into professional employment.
As part of the programme apprentices complete a work-based project in year 2, which will help them to develop their analytical and problemsolving skills, and which will also

directly benefit the employing organisations. In addition to project work, the apprentices complete a variety of industry modules developed by the LAA consortium throughout program, which are then assessed to achieve certification.
For those seeking a career in this field, an apprenticeship is undoubtedly an attractive option. The apprentice gets an overview of the profession, gains practical work experience, and acquires the necessary qualifications while earning a salary.
What are the Apprentiechip entry requirements?
• H7/O6 or above in five leaving certificate (or equivalent) subjects. A minimum of grade O6 must be obtained in English. A minimum of grade O6 or a B2 or above in Foundation level must be obtained in mathematics
• Holders of a QQI Level 5 or Level 6 (or equivalent) in cognate areas
• Applicants may also be eligible to become apprentices via Recognition of Prior Learning
Interested in applying for the apprenticeship?
The next apprenticeship intake will take place in September 2024, and employers are already beginning their recruitment drives.
The first step toward becoming an apprentice is to register your interest at www.laa.ie or to contact us by email: info@laa.ie
Upon registering, you will receive an information pack containing tips on finding job placement and a list of registered companies as well as email notifications of apprenticeship position openings
More information can be found at www.laa.ie
Sarah Ryan Logistic Apprentice, Hamilton Shipping
My interest in logistics attracted me to the Logistics Associate Apprenticeship.
The best part of the apprenticeship is working with industry experts who provide mentoring throughout the programme.
As part of my role, I am responsible for Imports and exports in both air and sea freight, and I'm gaining vast experience as I learn more about these aspects of freight forwarding.
The Logistics Associate Apprenticeship is a great way to earn while you learn, gain work experience, and get to experience life at a college at the same time. Anyone considering a career in logistics should consider this apprenticeship.

Shane Buckley Logistics & Supply Chain Apprentice. DPD lreland
I decided to Join the Logistics Associate Apprenticeship as I wanted to further my career in the logistics world, and I thought that the apprenticeship would be the best way to do it.
The apprenticeship is a great way to learn and obtain an Industry qualification while earning a salary at the same time.
Anyone who wants to advance a career in logistics should consider this programme and I highly recommend it.
Kevin Casey Logistics Apprentice, DSV
As a Working professional, I decided that the Apprenticeship would be the best way for rne to broaden my knowledge, enhance my skills, and earn a qualification in logistics that will benefit both my career development and my employer.
Throughout my apprenticeship journey, my employer has been very supportive and encouraging. Being able to attend college one day a week during working hours, and being reimbursed for my annual college registration fees by my employer, has given me a sense of great value as an employee.
The programme provides apprentices the opportunity to develop their skills, learn about the industry, and put what they have learned in college into practice in their workplace.
I highly recommend the Logistics Associate Apprenticeship programme to both future candidates and logistics companies.

THERE has been an increase in apprenticeship programmes across every sector in recent years, and with the launch of the Transport Operations & Commercial Driving apprenticeship, the transport sector is no different.
Industry heads hope that this training programme will go some way towards changing the perception of commercial driving as a profession, through creating awareness in schools by informing parents and career guidance counsellors of the varied driving roles within the freight distribution sector which offer rewarding and challenging career opportunities.
A huge difference
The programme started in September 2022 with 21 apprentices and Aidan Flynn, Chairperson of the Transport Operations & Commercial Driving Apprenticeship, says it will make a ‘huge difference to the industry’.
“This new apprenticeship will serve to be the catalyst to attract young people and vitally more women into our industry to support business growth,” he said. “The academic qualification offers validity and value to the profession of driving and it will

support career progression opportunities within the workforce.
"The Transport Operations and Commercial Driving apprenticeship is unique in that it is a fully funded academic qualification as well as covering the costs of HGV driving lessons and driving tests"
“In addition, while the average size haulage business has just over five trucks, this programme can support succession planning, with sons or daughters gaining a business qualification whilst attaining their driving licence and supporting the legacy of their family business.
“Also, having more education and training options in our sector, supported by the collaborative focus of the logistics and supply chain skills forum, will support Irelands ambitions to be leaders in supply chain and logistics.”
Along with benefitting the industry as a whole, this new apprenticeship, which is delivered by ATU Sligo, is also a great opportunity for both participants and employers and since its launch, it has attracted a great deal of interest.

“An apprenticeship is a way for both young people and adult learners to earn while they learn,” said Flynn. “The Transport Operations & Commercial Driving Apprenticeship is designed to deliver upon the industry need to attract more entrants to the profession of commercial driving, sow the seed for lifelong learning and support ca reer progression opportunities for the apprentice through the attainment of a Level 6 Higher Certificate in Transport Services and Commercial Driving.
“For an employer, hiring apprentices helps businesses to grow their own talent by developing a motivated, skilled and qualified workforce
–and we have been inundated with enquiries from employers and potential apprentices so we hope that we will see increased numbers starting the apprenticeship year on year.”
“To avail of this ‘earn as you learn’ apprenticeship the apprentice must be in full time employment and the employer must be approved by ‘SOLAS’ as fit to train apprentices. There are many employers looking to recruit apprentices which is supported by an apprenticeship employer grant of €2,000 per apprentice per year.”
With over 40,000 Irish registered Heavy Goods Vehicles, greater than 3.5 tonnes, on the roads in Ireland, Flynn hopes that this new programme will also raise awareness of the important role commercial drivers play in today’s society as they keep supply chains, across all sectors, open and flowing smoothly.
To this end, the new apprenticeship programme, which covers both practical work experience and online learning, is open to both the haulage and own account sector and covers a ‘significant variety of roles’ including working as a tipper driver for a construction company, delivering fuel to homes, national and international haulage, retail distribution, working in the waste management sector or even the entertainment industry.
“One of the main objectives of any apprenticeship programme is to support a sustainable and skilled workforce for employers and to support career progression opportunities for the apprentices,” he said. “In addition, apprenticeships sow the seed for lifelong learning which further supports and enhances the employer’s workspace and the employees’ ambitions.”
According to Flynn, the transport

and logistics sector has been less successful than others in recruiting younger workers over the years due to many factors ‘including a perception that it is made up of predominantly low skilled jobs required to work long hours’.
This, along with a lack of diversity within the profession, is another reason why this new programme is essential.
More women needed
“According to Road Safety Authority data, there are over 200,000 Heavy Goods Vehicle licences issued in Ireland and only 2% are issued to women in both C & CE category - this must change,” he said.
“Another concern is that over 60% of HGV full licences holders are over the age of 50 – so the importance of training and education in shaping the image of driving as a profession and attracting younger people into the profession cannot be understated.
“The Earn as you Learn apprenticeship offers great benefits to apprentices and employers alike. College isn’t for everyone, and these new apprenticeships offer young people the opportunities to get employment with the added benefit of earning a qualification on the national framework of qualifications at the same time.
"The Transport Operations and Commercial Driving apprenticeship is unique in that it is a fully funded academic qualification as well as covering the costs of HGV driving lessons and driving tests. So, the apprentices will qualify with a higher certificate in Transport Operations and Commercial Driving as well as a Full C & CE Category Driving licence and DRIVER CPC qualifications.
For more information visit www.cdap.ie, email info@cdap.ie or call 018447516





The Transport Operations & Commercial Driving Apprenticeship provides the academic qualification and practical training and work experience that supports a vibrant and exciting career in the freight distribution and logistics sector. Apprentices will also receive expert driving lessons and training in advance of completing their C/CE driving test and attaining the Driver CPC qualification.
The academic award for this apprenticeship is a Higher Certificate (NFQ level 6) in Business in Transport Services and is the first qualification on the national framework of qualifications (NFQ) linked to the profession of commercial driving!

✔ QQI Level 6 Award ‘Higher Certificate in Transport Operations & Commercial Driving’.
✔ Internationally recognised qualification.
✔ Earn as you Learn.
✔ Two year employment contract leading to permanent position.
✔ Gaining valuable on the job experience and workplace skills.
✔ Excellent Career Opportunities in the vibrant sector.

• Hold a Full ‘B’ Driver Licence.
• Be at least 18 years of age.
• Meet medical requirements for driving.


✔ Attracts new entrants into the business.
✔ Increases pool of qualified people within the business.
✔ Help with succession planning.
✔ The programme is built around work related experience and work specific projects.
✔ Apprenticeship State Grant for employers of apprentices €4,000 funding.


• Minimum entry requirements are a grade H7/O6 or above in five Leaving Certificate (or equivalent) subjects.
A minimum of grade O6 must be obtained in English.
A minimum of grade O6 or a B2 or above in Foundation level must be obtained in Mathematics.
• Holders of a QQI Level 5 or Level 6 (or equivalent) in cognate areas (eg business, logistics and distribution, supply chain management, etc.) can apply for entry onto year 1 of the programme.
• A mature candidate, over the age of 23, who does not hold qualifications as set out above, but who: Has a minimum of two years’ experience working as a commercial driver.
Is recommended by their employer.
Demonstrates the correct attitudes, behaviours and literacy skills.



-Investing in Your Growth
-Hands-on Learning
-Continuous Professional Development
-Study and Exam Leave Paid
-Professional Bodies Fees Paid
-Diverse Learning Experiences
-Promotional Pathways
-Global Exposure /Opportunities to Work Abroad
-Blue-Chip Clients
-Scale of Projects
-Innovation and Collaboration
-Challenging Environment
-Connected Community
-Mechanical Engineering
-Electrical Engineering
-Quantity Surveying
-Building Information Modelling
-Health and Safety
-Accounting
-Procurement
You are an ambitious, driven, and motivated graduate. You are a proven self-starter with unparalleled determination, known for your ability to seamlessly collaborate within a team. Your excellent communication skills are just one facet of your remarkable talent. Your unyielding ambition fuels your desire for a career filled with exciting challenges and unparalleled opportunities to develop and showcase your skills and expertise.

-Electrical
-Electrical & Instrumentation
-Plumbing
-Pipefitting
-Earn while you learn
-QQI Level 6 qualification (internationally recognised) -Both theory & practical “hands on” experience -Career for life
-Opportunities to work overseas
-Opportunities to progress your career
Jones Engineering are the largest trainer of construction apprentices in Ireland with 300+ apprentices in our employment annually.
We are proud to say we have had two gold medal winners in the World Skills competition and a gold and a bronze medal winner in the Worldskills Ireland competition. Such competitions require skill and determination and we encourage and mentor our apprentices to become the best in their field.
•Minimum of five passes at leaving certificate level (must include mathematics)
• Successfully pass the Ishihara Colour Vision Test
•Valid manual handling & safepass certificates

AN BHFUIL tú ag tabhairt faoin Ardteistiméireacht i mbliana nó b’fhéidir gur mhaith leat dul chun cinn a dhéanamh i do chuid oideachais ach níl tú cinnte cad ba cheart duit a dhéanamh?
Cibé mian atá agat, tá níos mó ná 1,900 cúrsa ag Bord Oideachais agus Oiliúna Mhaigh Eo, Shligigh agus Liatroma (BOOMESL) le roghnú astu. Agus spriocdháta an CAO ag teannadh linn, féach ar an réimse leathan de roghanna oideachais BOOMESL agus cuirfear ar bhealach do leasa thú!
Is féidir do Lánchumas a Fhorbairt lenár gcúrsaí IarArdteistiméireachta (PLC)!
Cuireann Coláiste Breisoideachais agus Oiliúna Mhaigh Eo, Coláiste Thuaisceart Chonnacht, agus Coláiste Breisoideachais Shligigh cúrsaí Iar-Ardteistiméireachta (PLC) ar fáil ina gcuirtear deiseanna iontacha ar fáil do mhic léinn atá ag aistriú ó leibhéal na meánscoile go dtí an chéad chéim eile ina n-aistear oideachais. Freastalaíonn na cláir lánaimseartha seo a mhaireann ar feadh bliana ar ábhair éagsúla,
lena n-áirítear Gnó, Spórt, Grúmaeireacht Madraí, Altranas, Scéimh, Eolaíocht, Eachaíocht, Inbhuanaitheacht agus go leor eile!
Tá na cúrsaí seo deartha chun cothromaíocht a aimsiú idir taithí phraiticiúil, foghlaim acadúil, agus nochtadh oibre san fhíorshaol. Cuirfidh na cúrsaí seo cumasc ar leith ar fáil duit a dhéanfaidh cinnte de go bhfuil tú ullmhaithe go maith do na réimsí atá roghnaithe agat. Má tá saol na teicneolaíochta á bhfiosrú agat nó má tá aghaidh á tabhairt agat ar chúram sláinte agus altranas, nó más ag tabhairt faoi chumas cruthaitheach sna healaíona atá tú, tugann na cúrsaí seo deis duit do shuimeanna féin a oibriú amach agus a fhorbairt.
Tá na deiseanna Erasmus thar a bheith tarraingteach sna cúrsaí PLC toisc go ligeann siad duit leas a bhaint as socrúchán oibre íoctha thar lear a mhaireann trí seachtaine. Aitheanta ag an Dearbhú Cáilíochta agus Cáilíochtaí Éireann, aithnítear na cáilíochtaí go náisiúnta ach go hidirnáisiúnta araon, rud a chuireann réimse leathan féidearthachtaí ar fáil do mhic léinn.
Chomh maith leis sin, dóibh siúd atá sa tóir ar ardoideachas, cuireann Coláiste Breisoideachais agus Oiliúna Mhaigh Eo agus Coláiste Breisoideachais Shligigh an chéad bhliain de Chláir Tríú leibhéal ar fáil, ag cur bealach réidh ar fáil dóibh siúd atá ag iarraidh leanúint ar aghaidh lena n-aistear oideachais.
Cláir Tríú Leibhéal: Bealach ar Leith chuig an Ardoideachas
Is deis é an Clár Tríú Leibhéal chun céim ag an tríú leibhéal a bhaint amach. Murab ionann is cúrsaí céime traidisiúnta, is féidir leat iarratas a dhéanamh go díreach, rud a fhágann nach gá fanacht ar phointí CAO. Ag tosú ar do chéim i gColáiste Breisoideachais (1 -2 bhliain ag brath ar an gcúrsa a roghnaíonn tú), rachaidh tú ar aghaidh chuig Ardoideachas ansin chun do chéim a chríochnú. I measc na roghanna tá céimeanna i nGnó, Innealtóireacht Inbhuanaithe, Eolaíocht Saotharlainne agus bealach rochtana ar chéim altranais. Níl aon táillí ar fhreastal ar Choláiste Breisoideachais.
Osclaíonn an bealach solúbtha seo doirse go hinstitiúidí
ardoideachais éagsúla agus féidearthachtaí gairme gan teorainn.
Printíseachtaí: Tuill
Airgead agus Tú ag Foghlaim Murab ionann is gnáthchúrsaí coláiste, ligeann printíseacht duit airgead a thuilleamh agus le bheith cáilithe agus tú ag foghlaim ar an láthair oibre, rud a chuireann gairmeacha iontacha fiúntacha ar fáil. Nascann printíseacht foghlaim sa choláiste agus foghlaim obairbhunaithe i gcuideachta. Bíonn cáilíochtaí atá aitheanta ar bhonn idirnáisiúnta mar thoradh ar phrintíseachtaí. Tá níos mó ná 70 clár printíseachta ar fáil in Éirinn inniu i réimsí amhail Airgeadas, TFC, bithchógaisíocht, tógáil, innealtóireacht, fáilteachas agus crannadóireacht.
Soláthraíonn BOOMESL dhá phrintíseacht idirnáisiúnta - an Phrintíseacht um Dhíolacháin agus Printíseachtaí Búistéireachta Ceardaíochta. Chomh maith leis sin agus faoi réir bailíochtú, beidh an Phrintíseacht um Margaíocht Dhigiteach nua agus an Phrintíseacht um Theicneolaíochtaí Tumthacha ar
siúl ó lár 2024. Soláthraíonn BOOMESL printíseachtaí i nGruagaireacht, Cibearshlándáil, Forbairt Bogearraí, Leictreach, Commis Chef, Pluiméireacht, Cearpantóireacht agus
Siúinéireacht, Deisiúchán Creatlacha Feithicle, Innealtóireacht Líonra agus
Ionstraimíocht Leictreonach.
Téann BOOMESL i bpáirt le go leor fostóirí áitiúla agus náisiúnta, ag cinntiú go mbaineann an méid a fhoghlaimíonn tú go díreach leis an margadh fostaíochta. Ní hamháin go bhforbraíonn an comhoibriú seo scileanna luachmhara ach freastalaíonn sé ar an éileamh le haghaidh oibrithe oilte sna réimsí éagsúla. Is bealach iontach iad printíseachtaí chun tosú ag obair le scileanna láidre, rud a fhágann go bhfuil tú “réidh chun obair” agus ag cur leis an ngeilleagar ag an am céanna.
Le haghaidh níos mó eolais nó fiosruithe téigh i dteagmháil lenár bhfoireann trí ríomhphost ag apprenticeships@msletb.ie nó tabhair cuairt ar www. apprenticeships.ie.
Socrúcháin Oibre: Oiliúint a Bhaineann go Sonrach Le Post le haghaidh Aistrithe
Gan Locht
Cuireann Socrúcháin Oibre BOOMESL oiliúint a bhaineann go sonrach le post ar fáil, chomh maith le hoiliúint dhíreach le tréimhse shuntasach d’Fhoghlaim Obairbhunaithe (FOB) leis an bhfostóir. Is deiseanna lánaimseartha agus ar feadh na bliana iad seo dóibh siúd a théann isteach san fhórsa saothair den chéad uair a éascú. Áirítear Teiripe Scéimhe, Gruagaireacht, Táthú & Déantúsaíocht, Teicneoir Déantúsaíochta agus Bainisteoir Eachaíochta leis na socrúcháin oibre.
Dóibh siúd atá an-tugtha don spórt, cuirimid Forbairt Imreora FAI/BOO ar fáil a ligfidh d’fhoghlaimeoirí barr a gcumais a bhaint amach; chun gairm i bpeil phroifisiúnta a fhorbairt. Ullmhaíonn an clár rannpháirtithe freisin do ghairm bheatha sa tionscal spóirt agus fóillíochta chomh maith le hiad a spreagadh a leibhéal oideachais a fheabhsú agus barr a gcumais a bhaint amach.
Seirbhís Treorach Oideachais d’Aosaigh BOOMESL
An bhfuil tú in amhras maidir le do roghanna oideachais? Tá Seirbhís Treorach Oideachais d’Aosaigh BOOMESL anseo chun tacaíocht a thabhairt duit. Tá ár bhfoireann Treoirchomhairleoirí d’Aosaigh cairdiúil agus rúnda agus tá siad réidh chun comhairle phearsanta a thabhairt duit. Cé acu ag smaoineamh ar roghanna oideachais nó ag fiosrú
gairmeacha nua atá tú, nó má tá treoir ag teastáil uait maidir le cinntí tábhachtacha, tabharfaimid lántacaíocht duit. Eagraigh cruinniú i suíomh príobháideach lenár dtreoirchomhairleoirí a bhfuil taithí acu chun an tacaíocht atá uait a fháil.
Ná tabhair aghaidh ar na roghanna móra sin leat féin! Tá go leor romhat, agus táimid anseo chun tú a threorú. Tóg an chéad chéim i dtreo aistir oideachais níos dearfaí—téigh i
dteagmháil linn don treoir atá tuillte agat. Tabhair cuairt ar www.msletbadultguidance.ie chun an fhoireann is cóngaraí duit a aimsiú!
Dóibh siúd atá ag tosú amach, ag cur lena gcuid scileanna nó atá go díreach sa tóir ar athrú gairme - tá rogha ar fáil do gach duine ag BOOMESL. Téigh i dteagmháil linn ag www.msletb.ie nó cuir saorghlaoch ar 1800 100 100! Samhlaigh thú féin ag BOOMESL.

Bord Oideachais agus Oiliúna an Longfoirt agus na hIarmhí
Longford and Westmeath
Education and Training Board
LWETB’s Colleges of Further Education and Training deliver courses to over 9,000 learners each year and manages 10 campuses across the region. We are committed to meeting the diverse needs and aspirations of our learners. We want all our learners to Grow, Succeed and Achieve.
Our Adult Guidance and Information Service is available to help our learners make informed decisions about their education, career and employment paths. This service can greatly contribute to personal and professional development. If you have any questions about your options or want to meet with a Guidance Counsellor please contact adultguidance@lwetb.ie
Find your nearest campus and discover the wide variety of services and resources available:
CONNOLLY CAMPUS
043 334 5609 fetlongford@lwetb.ie
BALLYMAHON CAMPUS 090 643 2558 fetlongford@lwetb.ie
CLONOWN ROAD CAMPUS 090 650 0272 fetathlone@lwetb.ie
GARRYCASTLE CAMPUS 090 650 0060 fetathlone@lwetb.ie

GRANARD CAMPUS 043 668 6211 fetlongford@lwetb.ie
DELVIN CAMPUS 044 966 4289 info.yrd@lwetb.ie
O’GROWNEY DRIVE CAMPUS 044 934 7217 fetmullingar@lwetb.ie
MARLINSTOWN CAMPUS 044 934 2111 fetmullingar@lwetb.ie
MILLMOUNT PLC CAMPUS 044 934 0786 admin.mcc@lwetb.ie
KILBEGGAN CAMPUS 057 933 3471 info.yrk@lwetb.ie



We offered a wide range of courses including Apprenticeships, Traineeships, Post Leaving Certificate (PLC), Specific Skills Training, Local Training Initiatives, Specialist Training Provision, Youth Provision (Youthreach & Community Training Centres), Back to Education Initiative (BTEI), Community Education, Literacy Services, Evening Courses and English for Speakers of Other Languages (ESOL).
If you would like to find out more about our courses or to apply please visit www.fetchcourses.ie. If you have any questions please contact our Course Recruitment Team:
Phone: 090 650 0061

Email: courserecruitment@lwetb.ie
LWETB are delighted to be part of Generation Apprenticeship in collaboration with the National Apprenticeship Office and SOLAS. Apprenticeship combines learning in an education and training institution with work-based learning in a company. At least 50% of apprenticeship learning is completed in the workplace and leads to nationally recognised qualifications from Level 5 - Level 10 on the National Framework of Qualifications.
Apprentices ‘earn while they learn’ - they have an employment contract and are paid a salary for the duration of their apprenticeship training. There are 72 apprenticeships to choose from; the duration varies in length depending on the programme, lasting between two and four years.

If you are thinking of starting an apprenticeship or want to find out about what apprenticeship has to offer you, please contact us and we will advise and assist you:
Phone: 090 650 0062

Email: apprenticeship@lwetb.ie
Post Leaving Certificate (PLC) courses are full-time programmes for young people who have completed their Leaving Certificate, and for adults returning to education. The courses last one to two years and lead to an award on the National Framework of Qualifications at NFQ Level 5 or NFQ level 6.
PLC courses offer a mixture of practical work, academic work, and work experience. They develop technical and practical skills for an industryrecognised qualification. They also offer an alternative route to higher education and can give you the opportunity to try out a subject of interest to you.
If you are thinking of applying for a post leaving certificate course or want to find out more please contact:
LONGFORD: Longford College of Further Education and Training
Email: ngriffin.tcl@lwetb.ie
Website: www.longfordcfe.com
MULLINGAR: Millmount PLC Campus
Email: eoreilly.mcc@lwetb.ie
Website: www.mullingarcc.ie
To keep up to date with courses, news and events search “LWETB FET” on social media at: Phone: 044 934 2111



RAPID advances in technology and the shift toward sustainability— including a sustainable work-life balance—are driving people towards degree course alternatives that allow them to earn while learning. ESB Networks is lighting a path forward.
“I started college in September 2021, and quickly realised the course was not for me,” recalls Jamie McCourt.
“I took some time off to consider what I should do. I looked into the ESB Networks’ Electrical Apprenticeship, and the chance to earn while I learned sounded brilliant.”
Jamie is one of 280 apprentice electricians from all over the country, accepted into ESB Networks’ Electrical Apprenticeship programme since 2021. The four-year programme, which combines on-the-job training with college classroom work, has grown in recent years to meet the rising demand for skilled tradespeople.
“People are realising that graduat-

ing with a degree, debt and no clear path to employment is not necessarily the way to a rewarding career and fulfilling life,” says Kara Keenaghan, the Apprenticeship Programme Manager.
This shift in thinking parallels the transformation of the energy sector. New green energy policies have put electricity and ESB Networks at the forefront of decarbonising our economy. For ESB Network’ apprentices, the evolving energy landscape opens a world of extraordinary opportunities.
The evolving energy landscape opens a world of opportunity
“Upon completing the programme, apprentices have an internationally recognised, advanced Level 6 Electrical Trade Certificate,” explains Kara.
“And, they will also be a qualified Network Technician. Many go on to work with ESB Networks going on call, becoming Network Operators,
“Upon completing the programme, apprentices have an internationally recognised, advanced Level 6 Electrical Trade Certificate,”
Cable Joiners and Training Officers or with other companies including our fellow energy utilities here and abroad. The opportunities are unlimited.”
For Conor Fenlon, a graduate of the Apprenticeship Programme now working as an ESB Networks Technician, the opportunities for career stability, continued progression and variety were particularly attractive.
“No day is the same, that’s for sure,” says Conor, who served with the Defence Forces on a UN mission to Syria prior to joining the apprenticeship programme.
“I currently work in overhead line construction, so I do everything from building new connections, to line retirement and patrolling, to installing pole-mounted transformers.”
The variety of indoor and outdoor work, teamwork and great career opportunities are just some of the benefits of an ESB Networks’ Apprenticeship.

While the programme requires an element of physicality, it also demands logical thinking and team work.
“There is definitely an adventurous element to the job,” says Jamie. “We’ve learned to climb electricity poles and pylons, and how to drive all-terrain vehicles. But we are also highly focused on safety, so learning how to assess a situation is a big part of what we learn.”
And, since our current situation demands that we create a low carbon economy, ESB Networks apprentices are building careers with purpose.
“It’s not merely about learning a trade,” says Kara. “It’s about becoming part of a movement that is building a brighter, more sustainable future.”
For the ESB Networks Electrical Apprenticeship individuals aged 16 or over with a Junior or Leaving Certificate, or equivalent can apply.





By Ann Marrion
I HAVE worked in education in the greater Belfast area, teaching in secondary schools and as an Educational Psychol0glst (EP). Our union and professional body is the Association of Education Psychologists (AEP). I have been a Local and Regional Representative for the AEP.
In my long career, I have witnessed the detrimental effects of the 11 plus system in our s0ciety. However, there remains a widespread belief - a myth - that our education system here Is ·the best In the British Isles" - mainly due to the excellent exam results obtained by the small percentage of our pupils who attend selective "Good Schools". We hear these good results every August and think we're doing OK. As very many researchers and educational experts have pointed out this finding is at the expense of the very high numbers of pupils who leave school with little or no qualifications.
In 2016, the AEP passed a motion rejecting selective educati0n almost unanimously at our AGM in Belfast We are pleased to have support from our General Secretary, Dr Cath Lowther, at this conference.
Unfortunately, there is sparse research to show the psychological consequences caused by the transfer system. We all have anecdotaI evidence about the shame and sense of failure experienced by those who do not "qualify" and while many go on to have successful lives and careers, there are too many who do not, having been disillusioned and defeated by the process. Too many have disengaged with education and society.
Almost half of pupils do not take part in the process and are likely to have disengaged from an early age - often leading to generational disadvantage. About 40% of those who take the test do not qualify for the "Good Schools". At 30.5%, Northern Ireland has the largest population share with basic or no qualifications. The proportion of young pe0ple here who are NEETS, not in Education, Employment or Training, far outstrips that in Britain.
A recent rteport published by Professor Siobhan O Neill, Mental
Health Champion for Northern Ireland (as reported In the Irish News, 26 August, 2023), stated that almost half of the 16-year-olds suffer mental ill health. The research from the Young Life and Times and Kids Life and Times Survey 2023 showed that high proportions of pupils were concerned over pressures at school. The well-beling of eleven-year olds here has declined to its lowest scoring level since 2016. I am not suggesting that this is all due to our selection system, but I feel it can contribute to these findings.
The current 11 plus system came about largely on the recommendation of an Educational Psychologist, Sir Cyril Burt, in the 1940s. Burt recommended selection on the unsafe assumption that intelligence was a fixed entity and that a measure of IQ could be safely used to select pupils at eleven for different post-primary school systems. Burt's work was subsequently discredited and shown to be fraudulent.
Meanwhile, the idea of intelligence as fixed and immutable has been shown to be an unintelligent and erroneous concept that ignores the evidence and simply does not do justice to what human intelligence is. However, the establishment of the grammar system across the United Kingdom in the late 1940s was based on such flawed notions. Research has shown that children continue to develop cognitively as teenagers, and so it makes no sense to categorize them intellectually at eleven.
In England and Wales, selection at eleven to Grammar Schools was soon shown to produce an unfair and unpopular system. Following parental and political pressure, comprehensive schools were introduced in England and Wales in the 1960s. There have been variations over the years, but comprehensives generally remain popular in most areas. Attempts to reintroduce grammar schools failed.
Recent Ofsted reports show that the results of children in comprehensive schools are comparable with many grammar schools and also with academies in England (Ofsted Report, as featured in

an article in the Guardian, 3 August 2023, by Mabel BanfieldNwachi). Another study reported in The Guardian's Educational Review on the 28 August 2023 suggested that the best pupils do better by avoiding grammar schools, a finding based on a study of half a million pupils in England and their results in GSCEs in 2016.
What do parents here think of the transfer process? Parents generally want the best for their children. On this point, I would point to findings from a recent doctoral thesis by local Educational Psychologist, Dr Clare Kidston. She interviewed a local group of "transfer" parents. The parents reported that their children had experienced chronic and debilitating distress throughout their final years of primary school. Unable to identify clear positives from engaging with the transfer system, the parents felt highly conflicted about continuing with the process due to their children's negative experiences.
Parents perceived their options regarding transfer as limited at best, more of a burden than a choice. Parents want their children to go to a "Good School" and "good parenting" would require compliance with the transfer system. Many of the parents had paid for private tutors and entered both sets of tests, undermining notions that the process is seen as fair and objective.
These insights into the complexities of parents' perspectives regarding the transfer tests in Northern Ireland challenge political rhetoric conflating their engagement with free choice and demand. These parents really do not have a choice.
The reports of intense psychological and somatic distress during and after the tests suggest that academic selection is not a harmless process. However, the psychological and emotional consequences for individual children are not well known and to the extent that individual parents do not have reason to see the tests as harmful, they have no cause to push for core system change.
Clinical Psychologist Dr Tara Porter has worked in Child and Adolescent Mental Health Services CAMHS in England for 25-plus years. She teaches and writes about mental health in schools. She highlighted that children and young people are reporting how stressed and unhappy they are with their schoolwork and the pressure they are experiencing. Data from the Children's Society as part of the Good Childhood Report 2022 consistently shows a low and decreasing level of happiness with school. Dr Porter suggests that in the context of increased competition for academic success, a higher level of unhappiness in children would not be unexpected with the transfer selection process.
Professor Siobhan O Neill, Mental Health Champion (reported in the Irish News 14 June 2022), highlighted the compelling mental health arguments to end academic selection using transfer tests. In a 2018 survey, 92% of teachers described the tests as having a significant mental health impact. The tests discriminate against neurodiverse and disabled children.
Teachers speak about the need to rebuild pupils' self-confidence when they arrive in non-grammar schools. The very basis of wellbeing and the potential for harm is immense. Professor O Neill noted that in 2010, 83% of children said that they sat the tests "in order to get into a Good School".
It seems that parents, teachers and children are all impacted negatively by the transfer process here. Good parenting would dictate that parents should comply with a system which is highly stressful for all concerned. In a few local areas, transfer does not involve testing (Maghera, Ballycastle, Portadown), and I have heard that the experience is much more benign, but I have not been able to find concrete evidence to support this.
Parent Power may be needed to change the system. If all children transfer to their closest secondary school, the overall standards of education would be raised. The "Less Good Schools" should be funded to the level that all children receive a fair education.
Figure 3a: Enrolments in post-primaryschools in Northern Ireland - grammar/non-grammar split, 2013/14 to 2023/24
Source
I feel that the Educational Psychology Service and /or the Association of Educational Psychologists could convene a working group to contribute to ongoing debates with a psychological perspective and develop a position statement for the system in Northern Ireland. The mental health and wellbeing of pupils has to be at the forefront of the consideration for all including psychologists. Parents deserve to be informed about the consequences of the limited choices that the current transfer system brings.
The need for change
All the arguments point to the need for change in the education system in Northern Ireland. But if we don't have academic selection at eleven, what system could we have? One strategy is to identify an ideal future and then analyze what needs to be done to get there. I would like to outline what I see as an ideal starting point for post primary schools. This is easier than working out how to get there. Ideally ...
The system of using unofficial academic transfer testing is stopped. This would be a win for families, pupils and teachers; parents will be free from the stress and expense of tutoring; pupils will be freed from the stress and anxiety of testing; schools will be freed from pressure "to deliver good 11 plus results" through the training of some pupils for the test. Furthermore, a wider curriculum can be followed for all pupils, including those who are often labelled or perceived as failures early in their primary school years. My friend taught Primary One for years and was often asked early in Primary One, "Do you think he/she will pass the transfer?" With the selection process gone, siblings and friends would not be separated at eleven; the practice of excluding pupils with lower intellectual ability and many of those with special educational needs would end.
Pupils should transfer to the closest post-primary school. This will be a win for pupils, families, the environment and the economy. Many could walk. There are several small rural towns where up to 20 buses leave each day, going past a local school which could
accommodate them. This practice is at vast expense to the budgets, the environment and the time spent travelling.
Secondary schools could have mixed ability classes in a 'Junior High' School model (cf Dickson Plan, Portadown). At Key Stage 3, pupils could move towards local Vocational or Academic courses for Key Stage 4. After this, sixth form and vocational centres will follow to age 18/19. The educational outcomes for all pupils will be raised, and we will have a more educated workforce - a win for society and the economy and a better quality of life for all, especially our current large disaffected cohort.
This simple vision for secondary schools will need agreement from education systems, politicians, parents and churches. With current pressures from budgets and from climate change, it seems that arguments could easily be made to move away from our current position. We at Reclaim the Enlightenment feel that this is a model to deliver a just and equitable system for all children in Northern Ireland.
(A Change.org petition has been started - Eleven Plus - transfer test in Northern Ireland)

Ann Marrion (annmarrion1@yahoo.co.uk) is a retired Educational Pscholologist. She has worked in all school sectors, and taught in nongrammar secondary schools for many years.
Reclaim the Enlightenment is a cross community initiative which seeks to rediscover the radical, democratic and progressive spirit of the late 1700s in Belfast and Ireland. (reclaimtheenlightenment.net)

Education for Enlightenment - Is Our Education System Failing Our Children? was a conference held in Belfast in November 2023 and aimed at removing religious, class and social divisions and barriers to education in Northern Ireland.
OF FURTHER EDUCATION
CELEBRATING 20 YEARS OF EDUCATION AND TRAINING
Accredited QQI Level 5 & 6 Courses Open to all applicants. Apply now.
For enquiries regarding our courses contact our Guidance Counsellors: Derek Ball dball.dbc@lmetb.ie Meabh Nimmo mnimmo.dbc@lmetb.ie Course duration is 1 or 2 years depending on the course. All courses are full time requiring on campus attendance.
Healthcare
● Pre-University Nursing
● Healthcare Assistant
● Pre-Paramedic Fire and Ambulance (with PHECC EFR)
● Physiotherapy Assistant
● Pre-Occupational Therapy Studies/OT Assistant
● Pre-Speech and Language Therapy Studies
● Pharmacy Assistant
Social Care, Criminology and Psychology
● Social Studies/Social Care
● Youth and Community Work
● Applied Psychology with Criminology
● Criminology, Psychology with Law
● Security Studies and Criminology
Education and Childcare
● Early Learning and Care (Childcare)
● Pre-University Arts/Teaching
● Pre-University PE Teaching and Coaching
● Special Needs and Classroom Assistant Primary and Post Primary Science
● Pre-University Science
● Pre-University Agricultural Science
● Pre-University Biomedical and Pharmaceutical Science
● Pre-University Forensic Science
● Pre-University Environmental Science
● Pre-University Sports Science
● Pre-University Food Science, Nutrition, Health and Wellbeing
● Pre-University Animal Science
● Pre-University Physiotherapy
● Advanced Animal Science Law and Politics
● Pre-University Law
● Pre-University Law with Politics
● Pre-University Business Law
● Pre-University Politics, Economics and Social Science Arts
● Pre-University Arts
● Pre-University Liberal Arts
● Theatre Studies and Performance Animal & Equine
● Animal Care Assistant
● Equine Studies
● Advanced Equine Breeding (with Greencert)
● Advanced Pre-University Animal Science Engineering
● Pre-University Engineering


● Pre-University Business
● Advanced Pre-University Business
● Human Resource Management
● Pre-University Business, Finance and Accounting
● Accounting Technician Apprenticeship
● Auctioneering, Valuation and Estate Agency
● Logistics and Distribution
● Office Administration - Legal and Medical Secretary
● Office Accounts, Administration and Information Processing
● Tourism and Business with Event Management
● Online Marketing / eBusiness Computing & Technology
● Software Development and Games Design
● Pre-University Computer Network Systems
● Creative Digital Media
● Augmented and Virtual Reality Visual Art & Design
● Art and Design with Portfolio
● Animation
● Higher National Diploma in The Animation Industry
● Graphic Design
● Architectural Technology and Design Music & Sound
● Music Performance
● Sound Production
● Higher National Diploma in Artist Development for Musicians
● Higher National Diploma in Sound Engineering Film & Media
● Media and Film Production
● Higher National Diploma in Film Production
● Journalism, Digital Media and Public Relations Hospitality & Tourism
● Tourism and Business with Event Management
● Tourism and Airline Studies
● Professional Cookery
● Beauty and Hairdressing
● Beauty Therapy
● Pre-Apprenticeship Hairdressing
● Hairdressing Apprenticeship
● Advanced Beauty Therapy Sports
● Pre-University PE Teaching and Coaching
● Sports Management with Business
● Personal Training and Fitness Instruction

● Sports Rehabilitation and Physiotherapy Assistant




SUSTAINABLE TRANSPORT ENGINEERING

“Our Fully funded 29 week Level 5 Diploma in Sustainable Transport Engineering is the perfect stepping stone to achieving an Engineering Degree”
“Join the course with as little as a junior certificate and in less than 4 years you can secure your degree”
KEVIN STUART TRAINOR
BICYCLE ENGINEERING ACADEMY CENTRE MANAGER
Our engineering diploma gives learners a unique proven pathway to third level education.
The course is aimed at learners : Who maybe didn't reach the desired level of CAO points for their chosen course
Adult learners looking to return to education

Are there any financial supports in place for the students?
Tuition costs are fully covered by the Limerick Clare Education Training Board (LCETB)
Students currently in receipt of social welfare will not have there payments effected by enrolling in any of our courses



Early school leavers looking to renter education (minimum Junior certificate) Learners who would like to sample a wide range of Engineering disciplines before commiting to a degree program
On completion of the Diploma learners can:
Continue in education through our proven degree pathway with TUS (Technical University Shannon)
Learners have the option to potentially join year 2 of a three or four year degree course.
Enter employment in the Engineering or cycling industry
www bea ie
Students not in receipt of social welfare may be entitled to: Training Allowance Travel Allowance
Design, fabricate and Braze your very own bicycle frame while learning key engineering skills such as: Brazing
Metal fabrication
Engineering trigonometry
Engineering principles
What certificates will i gain on successful completion of the course?
All our qualifications are issued by internationally recognised City & Guilds
2850-34 Level 3 Diploma in Mechanical
Manufacturing Engineering
2850-301 Health & Safety
2850-302 Engineering Principles
2850-307 Manufacturing Engineering
2850-312 Tig Welding Of Materials
2850-327 Detailed Fitting Of Materials
2850-329 3D CAD
528-12 Skills Foundation certificate in Electronic Engineering
5546-02 City & Guilds Award in Employability Skills (Preparing for Employment)
3902-28 Level 2 In Cycle Mechanics
Advanced Bicycle Technician & E-Bike dvanced Technician, E-Bike & PPT
Bicycle Engineering Academy
Certificate of Completion

PROVEN PATHWAY TO THIRD LEVEL EDUCATION (BACHELOR OF ENGINEERING)

SUSTAINABLE TRANSPORT ENGINEERING
Mechanical Engineering
Electronic Engineering
3D Design (Fusion 360)
Tig Welding & Brazing
CNC
3D Printing
Advanced Bicycle Mechanics
Frame
Building & Design
Employability Skills
Business Skills
Proven Pathway To Third Level (TUS)
Fully Funded By LCETB
Open To All 16+
Covers Various Engineering Disciplines
Business Startup Guidance
Design & Build Your Own Bicycle Frame (Brazing)
Early School Leaver
Return To Education
Mature Student
Inclusive To All Individuals
Upskilling To Advance
Parent Returning To Education
Training Allowance
Accommodation Allowance
Travel Allowance
Subsistence Allowance
Social Welfare Payments Are NOT Effected
Education Assistance Support




CRUMLIN College of Further Education has been providing a quality educational experience to students in South Dublin and beyond for almost 70 years.
Located on Crumlin Road, its close proximity to Dublin Bus and Luas services makes it an ideal location for students. A range of QQI courses are offered at Level 5 and Level 6 in the schools of Hairdressing , Beauty , Fashion, Fitness & Sports Therapy, Information Technology, Business, Administration & Accounting , Tourism, Catering.
In addition, a range of night courses are offered at its Evening School. Here’s just a flavour of what’s on offer at Crumlin College….
The Fashion Department in Crumlin College offers industry focused courses that reflect the current and future staffing requirements of the business and creative sectors of the fashion industry. Students can choose between the QQI Level 5 course in Fashion Buying & Merchandising or Fashion Design with Styling. Both courses offer students a comprehensive understanding of their chosen field as well as a rounded perspective on the fashion industry as a whole.
The college has established close links with a network of professionals within the fashion industry. Research field-trips for college assignments are organised throughout the academic year and are enjoyable and valuable learning experiences.
Students have the opportunity to
get hands-on experience through the college’s work experience programme. There is also the possibility to apply for college-organised internships and work-experience placements in major international Buying & Merchandising offices.
Through the college’s industry links with some of Ireland’s leading fashion designers and fashion stylists, there are frequent opportunities to apply to gain practical hands-on experience in fashion design studios or in assisting in the styling of fashion shows and photo shoots.
Upon successful completion of the QQI Level 5 course, many graduates have successfully gained employment in the fashion industry as Trainee Buyer & Merchandisers, Assistant Stylists or Design Studio Assistants. Through the QQI progression routes, graduates may also apply to third level courses.
Crumlin College graduates may progress to the BA in Visual Merchandising & Display at TUD. There is also the option to progress onto the QQI Level 6 course in Fashion Management in Crumlin College and this will appeal to students who wish to develop a career in the business, managerial and retailing side of the fashion industry while actively developing imagination and flair for design, buying and selling.
The dynamic and industry-focused courses offered by Crumlin College’s Fashion Department equip graduates with a well-rounded and practical skill-set desired by prospective employers in the fashion industry and prepares them for study at third level institutions.
"The dynamic and industryfocused courses offered by Crumlin College’s Fashion Department equip graduates with a well-rounded and practical skill-set desired by prospective employers in the fashion industry"

"Students get a solid grounding in the practical side of Culinary Arts and participate in a work experience programme"
The School of Beauty is located in a separate building in Captain’s Road, Crumlin. Crumlin College offers a one or two-year Diploma in Beauty Therapy . The Diploma in Beauty Therapy includes accreditation from QQI, ITEC and CIDESCO.
The course provides intensive practical and theoretical training in a various aspects of Beauty Therapy and leads to an internationally recognised qualification. Successful applicants can attain employment as a beauty therapist in a broad range of industries including Cruise Liners, Beauty Salons and Health and Leisure centres.
This is an exciting new opportunity for beauty therapy students which combines in-class teaching with learning on the job. The QQI Level 5 Beauty Therapy award offers a broad range of business and beauty modules to students working in the beauty industry and provides them with the necessary skills and knowledge to progress within their careers.
Students have the option of choosing the Culinary Arts (Professional Cookery) Programme or the Commis Chef Apprenticeship
The Culinary Arts (Professional Cookery) is a one year course at QQI Level 5 with the possibility to progress to a second year at QQI Level 6.Students get a solid grounding in the practical side of Culinary Arts and participate in a work experience programme which allows them to

further hone the skills acquired in class.
On successful completion of the course, students may progress on to a range of higher certificate and degree courses in Institutes of Technology or Universities.
Alternatively, they will have acquired the necessary skills to take up employment in a broad range of hospitality organisations, a sector of industry where suitably qualified applicants continue to be in high demand.
Crumlin College is just one of two colleges in Dublin offering the Commis Chefs Apprenticeship Programme . This is a 2 year programme for chefs who are already working in industry.
A combination of practical and theory based learning both on and off the job leads successful graduates to a Level 6 QQI Qualification in Culinary Arts.
The following are just some of the other courses on offer at the college:
Pre-Degree Computing
A QQI Level 5 course that prepares learners for entry into Level 7/8 Degree programmes in Information Technology at Higher Education Institutes. Students who successfully complete the course will have attained the necessary skills to enter the workforce as junior programmers or in IT systems supports roles.
Sports Injury Prevention and Message Therapy
This course is designed to provide the knowledge and practical skills
"Crumlin College is just one of two colleges in Dublin offering the Commis Chefs Apprenticeship Programme"

"Students are able to equip themselves with internationally recognised qualifications and can avail of employment opportunities in the fitness, health and leisure industries"

required to work in the Sports & Leisure sectors. It consists of theoretical and practical training which enables students to work in Health Spas & Massage Therapy Clinics.
Candidates who successfully complete the course will receive internationally recognised accreditations from both QQI and ITEC.
gress to Fitness Instruction and Personal Training Year 2 in the college or may progress to degree courses.
Crumlin College of Further Education, Crumlin Road, Dublin 12
Crumlin College also offers one year QQI Level 5 in Hairdressing and the 3 year National Hairdressing Apprenticeship.
Coláiste Breisoideachais Croimghlinne, Bóthar Croimghlinne, Baile Átha Cliath 12
This QQI Level 5 course, with additional accreditation by ITEC, allows for progression onto the Level 6 Fitness Instruction & Personal Training Course at the college.
Students are able to equip themselves with internationally recognised qualifications and can avail of employment opportunities in
Further information can be found about the apprenticeship on hairdressingapprenticeship.ie/


Students who successfully complete the course can seek employment in areas such as sports marketing, sports development and fitness instruction.
Alternatively, students may pro-
For information on these and all our courses and for a seamless application process, you can visit online at www.crumlincollege.ie and click on the Apply Now link. For all courses beginning in September 2024, students only pay a €50 registration fee, making Further Education an affordable way to pursue your academic and career goals.
To access regular updates about what’s happening at the college, visit the home page of the website where there are links to all the social media platforms used.
Alternatively, you can call the college directly at 01 4540662 where a member of our helpful team will be available to answer any queries you may have.


PRE-UNIVERSITY courses, direct access to the jobs market and apprenticeships are some of the key reasons students attend Blackrock Further Education Institute.
With the Taoiseach Simon Harris stating, when he was Minister for Higher Education, that there is too much emphasis on traditional educational pathways, attention rightly turned towards alternatives to the CAO, and the Further Education sector is leading the charge. Students, career guidance counsellors, parents, the media and wider society are sitting up and taking notice.
BFEI has worked hard to develop an access route for students who wish to gain degrees. Recent data has shown that three out of four BFEI students who applied through the CAO in 2023 get offered a place, the majority on Level 8 courses.
Their Pre-University Law QQI Level 5 course, now in its seventh year, can boast of past pupils taking places in university law courses across the country from TCD to NUIG.
The Pre-University Arts and Social Studies programme aims to do the same for students who wish to become teachers, social workers or NGO employees but missed their
CAO target.
These alternatives to the Leaving Certificate/CAO route are a valuable lifeline and pressure release valve for so many students, and BFEI has many years' experience in successfully delivering these courses and helping students achieve their goals.
Their Psychology course is another example of where BFEI excels. BFEI have been running their Level 5 course in Psychology for over 16 years and this has facilitated many students to progress on to degree and masters level courses in DCU, UCD, SETU (Southeast Technological University), DLIADT, Maynooth, to name but a few.
Due to the success of these courses, BFEI now runs similar programmes in IT and Business and Design all with the same aim: start your studies in BFEI and then complete them in your choice from a wide range of other colleges.
Direct progression into the workplace on courses such as IT, Beauty and Body Therapy, Nails and Lashes and Over the Counter Pharmacy Assistant, has long been a feature of the success of BFEI.
The list of household names that have graduated from the beauty
"BFEI has worked hard to develop an access route for students who wish to gain degrees.
Recent data has shown that three out of four BFEI students who applied through the CAO in 2023 get offered a place"
courses in BFEI include Suzanne Jackson, Jennifer Rock (The Skin Nerd), Rose Connolly, Michelle Regazzoli (Mrs Makeup) and Caolán Kelly (RTE Glow Up Ireland 2021 contestant). Not to mention the many students that go directly into salons and pharmacies in Ireland and abroad with confidence from having a widely recognised qualification under their belts.
In 2016, together with Accounting Technicians Ireland, BFEI began its Accounting Technician Apprenticeship. Students qualify after two years as an Accounting Technician and can progress to a Level 9 course with Chartered Accountants Ireland.
Students study one day a week in BFEI and work four days a week with employers who have included ESB, Grant Thornton, OSK and Revenue, earning a salary starting at €20,000. The symbiosis between the classroom and the workplace benefits the students greatly and is evident in their satisfaction with this method of learning.
Easy Application: If you wish to apply to any course in BFEI it is as simple as logging on to their website (www.BFEI.ie) and completing a free online application.





SCFE is pleased to announce the following new courses commencing in September 2024
1.Advanced Training in Special Needs Assisting and Inclusion
2.Yoga Teaching including Wellbeing and Holistic Studies (ITEC Certified)
3.Pilates Teacher Training with Sports Rehabilitation (including Sports Massage and Physiotherapy Assistant)
SCFE Offers Advanced Training in Special Needs Assisting and Inclusion
Sallynoggin College of Further Education (SCFE) is delighted to announce the introduction of its Advanced Training in Special Needs Assisting and Inclusion QQI Level 6 course, commencing in September 2024. This programme builds upon the success of our established Special Needs Assisting and Intellectual Disability Studies QQI Level 5 qualification.
The Advanced course equips participants with the knowledge and practical skills necessary to excel as Special Needs Assistants (SNAs) within diverse educational and care settings. Graduates will be prepared to support individuals with disabilities in primary and secondary schools, as well as community and healthcare service environments.
Course Benefits:
• The in-depth curriculum is enhanced through valuable realworld experiences such as educational field trips, specialised workshops, guest speaker presentations, and a mandatory work experience placement in local schools or services such as St John of Gods.
• Participants will gain essential certifications in Lámh Sign
Language, Occupational First Aid, and Manual Handling.
For more information on our Level 5 and 6 Special Needs Assisting Course, please see our website on www.scfe.ie or contact reception@ scfe.ie.
By choosing SCFE to complete a Level 6 program, students will delve deeper into their chosen field, gaining a more comprehensive understanding and a wider range of skills. This translates to a significant boost in their employability, making them highly sought-after by employers seeking qualified candidates.
The extended program duration allows for more substantial and diverse work placements, providing invaluable real-world experience. Ultimately, these two years of indepth learning and practical application empower students to confidently explore their career interests and make well-informed decisions about their future.
While students graduating from a Level 6 are work-ready, some may choose to progress to Higher Education at levels 7 and 8. SCFE has excellent progression links to HE and our students who have completed a PLC are well prepared for success in Degree courses.
SCFE's renowned Yoga Teacher Training program is excited to announce a significant enhancement for our course commencing in September 2024. Building on the programme's established success, SCFE has integrated a new qualification in Complementary Therapies,
"By choosing SCFE to complete a Level 6 program, students will delve deeper into their chosen field, gaining a more comprehensive understanding and a wider range of skills."
giving graduates a more comprehensive skillset for a flourishing career in the wellness field.
The new Yoga Teaching including Wellbeing and Holistic Studies course offers a comprehensive learning experience. Students will earn the prestigious ITEC Level 3 Diploma in Yoga Teaching, along with the ITEC Level 3 Diploma in Complementary Therapy Treatments. This dual qualification equips graduates with the knowledge and practical skills to excel as both yoga teachers and complementary therapists.
The program covers the core aspects of yoga teacher training, including programming and delivering yoga sessions, while simultaneously exploring complementary therapies like Reflexology, Body Massage, and Aromatherapy. Students can refine their teaching skills by delivering yoga classes in various settings, gain practical experience through work placements, and learn from industry experts through guest speaker sessions and holistic workshops.
Graduates of the program will be well-positioned to pursue different career paths such as establishing a yoga teaching business, setting up a


private practice offering complementary therapies, or working within spa and leisure centers and alternative therapy clinics.
A Student's Perspective:
Joanne Reid, a graduate of the SCFE Yoga program, shares her experience:
"The SCFE Yoga course was a transformative experience that exceeded my expectations."
For more information on our new Yoga Teacher Training course and our part-time BTEI course, see our website www.scfe.ie.
SCFE Enhances Pilates Teacher Training Program with Sports Rehabilitation and Massage Therapy Integration
Sallynoggin College of Further Education (SCFE) has also significantly added to its existing Pilates Teacher Training program commencing in September 2024. SCFE has integrated Sports Rehabilitation and Massage Therapy into the curriculum, providing graduates with a comprehensive and in-demand skillset.
A Multifaceted Qualification:
The program offers a unique combination of internationally recognized qualifications. Upon successful completion, graduates will earn the ITEC Level 3 Diploma in Pilates Teaching alongside the ITEC Level 3 Diploma in Sports Massage. This enhanced
qualification equips graduates with the theoretical knowledge and practical skills to excel as both Pilates instructors and Sports Massage therapists.
Enriched Learning Experience:
The program curriculum encompasses the core tenets of Pilates teacher training, including the programming and delivery of effective Pilates sessions. Students will explore the scientific underpinnings of sports massage, gaining expertise in specific treatment techniques, sports-related anatomy and physiology, and crucially, injury prevention strategies. An additional QQI Component Award Level 5 in Physiotherapy Assisting will equip them with a well-rounded foundation in movement science and therapeutic interventions.
This comprehensive program opens doors to a multitude of promising career paths. Graduates can opt to establish their own Pilates studios, secure employment within established settings such as sports clubs, leisure centers, and healthcare facilities, or embark on private practice as sports massage therapists.
A Graduate's Testimonial:
Aoife Byrne, a graduate of the Pilates program and current instructor at Flow Fitness in Bray, states:
"The opportunity to commence teaching under supervision from the
"The opportunity to commence teaching under supervision from the outset was exceptional preparation for the realities of the profession. The learning environment was both supportive and stimulating."
outset was exceptional preparation for the realities of the profession. The learning environment was both supportive and stimulating. The instructors were fantastic, and I am thrilled to have completed the program.”
For more information on our Pilates Teacher Training including Wellbeing and Holistic Studies, please visit our website at www.scfe.ie
SCFE offers a wide range of courses across our departments of Childhood Education, Sport and Fitness, Performing Arts, Social Studies, Fashion, Creative Arts, Hair and Beauty and Travel and Tourism
Our courses blend academic excellence, practical experience through programs like Erasmus+, and a vibrant student life that prioritizes well-being. SCFE equips students with the skills and experiences they need to thrive in the workplace and beyond.
Explore our course offerings online at www.scfe.ie or contact Reception at Reception@scfe.ie or Tel: 01 285 2997.
We also invite you to come and visit us on our next Open Day on 28th August 2024. The college has free car-parking and is served by a number of bus routes from Dun Laoghaire.

THE Higher Education Access Route (HEAR) is a college and university scheme that offers places on reduced points and extra college support to school leavers from socio-economically disadvantaged backgrounds who are resident in the Republic of Ireland.
HEAR was set up to tackle educational disadvantage. Socio-economic disadvantage negatively impacts on educational attainment at school and affects progression by some second level students to third level. Research in Ireland shows that, for example, the son/daughter of an unskilled manual worker (e.g. factory worker) is less likely to progress to higher education than the son/daughter of a higher professional (e.g. doctor).
HEAR is for school leavers under the age of 23 as of 1 January 2025 who are resident in the Republic of Ireland. Mature and FET (Further Education and Training) students have their own admissions routes and should contact college admissions offices for more information. Applications to HEAR can only be made online through the CAO.
If you apply to HEAR and meet the application criteria (that is, are deemed eligible for HEAR) you may be offered a place even if you do not have enough Leaving Certificate points for your preferred course. Each participating college and university has a reserved number of places to offer eligible HEAR applicants at lower or reduced Leaving Certificate points.
An example of a reduced points offer is that the Leaving Certificate points for a particular course is 366 points. An eligible HEAR applicant could be offered a place with a lower points score, e.g. 356 points.
This applicant would also, like all other applicants applying to college, need to meet the minimum entry requirements and any specific pro-
"Research in Ireland shows that, for example, the son/daughter of an unskilled manual worker is less likely to progress to higher education than the son/ daughter of a higher professional"
gramme requirements before being considered for a HEAR reduced points offer. The reduction in points for HEAR places can vary every year. The number of points a particular course is reduced by is dependent on a number of factors, such as:
•The overall number of places on the course.
•The number of reserved HEAR places on the course.
•The number of HEAR eligible applicants competing for these reserved places.
Information on the number of reduced points places available per
course and the method used by colleges for selecting eligible HEAR students for those places is available on some HEI websites and on the page of each of the participating colleges on the accesscollege.ie site.
If you get a place through HEAR, you will receive a variety of academic, personal and social supports while at college.
College supports may include:
•An Orientation Programme to introduce you to university/ college.


•Extra tuition if required, study skills and exam preparation.
•One-to-one meetings with student advisers.
•Social gatherings/mentoring.
•Extra financial assistance when available/advice regarding grants and scholarships.
Prioritisation of Applicants
Eligible for both DARE & HEAR
Research has shown that students with disabilities from disadvantaged backgrounds face the greatest obstacles when it comes to progression to higher education.
In order to increase the numbers of students facing this ‘double disadvantage’, colleges participating in DARE and HEAR have agreed to prioritise this group when allocating reduced points places.
What HEAR is not
HEAR is not your maintenance grant (SUSI grant). The maintenance grant is the main source of financial assistance available from the Irish State for students in full-time Post Leaving Certificate Courses (PLCs) and full-time higher education undergraduate courses. HEAR is an
"In order to increase the numbers of students facing this ‘double disadvantage’, colleges participating in DARE and HEAR have agreed to prioritise this group when allocating reduced points places"
admissions scheme to help students who may not traditionally go on to third level.
Financial Assistance and SUSI
Students applying to HEAR are encouraged to find out more information on the maintenance grant. Additional information on other sources of financial assistance for third level students is available at www.studentfinance.ie.
Should I apply?
HEAR applicants must meet a range of financial, social and cultural indicators (criteria) to be considered for a reduced points place and extra college support.
1. Income: Your family income falls on or below the HEAR Income Limit for the year 2023 (see page 4 of the hear booklet for details of the HEAR Income Limit).
2. Medical/GP Visit Card: Your family has a Medical Card/GP Visit Card that was in date on 31 December 2024.
3. Means Tested Social Welfare: Your family received a means-tested
payment from the Department of Social Protection for at least 26 weeks in 2023.
4. Socio-economic Group: You belong to a group that is underrepresented in higher education based on the occupation and employment status of your parent(s) or guardian(s). The underrepresented groups are the Non-Manual Workers Group and the Semi and Unskilled Manual Workers Group.
5. DEIS School Attendance: You completed five years in a secondlevel school that takes part in the Delivering Equality of Opportunity in Schools (DEIS) scheme run by the Department of Education and Skills.
6. Area Profile: You live in an area where there is concentrated disadvantage – in other words an area where, for example, there is high unemployment and poverty and where only a small proportion of adults have attained third level education.
Comprehensive information on the HEAR scheme is available at www.accesscollege.ie


Teaching creative thinking skills is a vital part of our children’s education
By Kim Mackenzie-Doyle, Founder & CEO, The B!G Idea
MORE than ever, the students in our classrooms today will need to be innovative, creative, and skilled in collaboration to tackle complex problems.
According to the World Economic Forum, LinkedIn and Forbes, creative thinking is the top skill required by businesses by 2025.
Despite this, how to think creatively - developing innovative solutions to challenges - is not yet firmly embedded into our education policies. Cultivating creative thinking is not just beneficial for business and industry but it’s also a critical skill for society, supporting people to navigate the inevitable challenges of everyday life.
So, how exactly can we foster creative thinking in our classrooms?
Enter The B!G Idea! - a free, multiaward-winning creative thinking education programme for 15-19 year olds that teaches adaptability, collaboration, critical thinking and creative problem solving. It has been embraced by Transition Year, Leaving Cert Applied and Youthreach programmes across the country.
The B!G Idea supports teachers and students to explore their creative potential and the role of creative thinking in the classroom. While taking part in the programme students learn how to come up with creative solutions to everyday challenges. They experience working as a team,
what can be learned from failure, how to interpret advice while learning skills and methods to help them devise B!G ideas.
At The B!G Idea, we firmly believe that we must teach our young people how to unlock their own creativity –to equip them with this essential life skill and enable them to reach their full potential. If we don’t, we will fall behind socially and economically as well as doing our young people a disservice.

Why do we need The B!G Idea?
We must think differently about the role of education. Together we need to create an environment for young people to realise their potential and become changemakers, innovators, leaders and trailblazers who can positively impact not only their own communities, but also wider society.
To show them new ways of learning, not just rote learning, which doesn’t accurately reflect the reality of life or the world of work.
The good news? The B!G Idea is shaking up the status quo - bridging the gap between education and business so that young people learn cutting-edge methodologies of how to develop new ideas and solutions to local and global challenges and the UN Sustainable Development Goals (SDGs).
Data gathered in 2023 once again demonstrates that
With support and advice from industry professionals, students move fluidly between imagination and logic, individual and group work. This gives them first-hand experience with the messy, nonlinear nature of real-world problem-solving.
“The most important thing we have learned is to always keep an open mind and to not see failure as a bad thing, but as a learning opportunity.”
The programme is facilitated by educators in various settings who in turn are supported fully through access to The B!G Idea online modules and classroom resources, as well as a free professional development workshop on creative and critical thinking skills.
We’re very proud of the fact that the initiative was recently praised in
an OECD report for promoting creative thinking skills in formal education as part of Ireland’s strategy to reduce the negative impact of student assessment regimes on the practice of creative thinking.
And the feedback has been overwhelmingly positive. Students love the programme while learning valuable skills and techniques. For me, one of the most inspiring impacts of the initiative is how it has given students confidence, belief in their own abilities and uncovered leaders who didn’t realise their innate capacity to nurture and encourage others.
As Michelle Howard, Tutor, Tullamore Community Training Centre put it about her students who had taken part: “They’ve completely changed their mindset on their lives and their goals. They now know they can have dreams.”
Students from Borris Vocational School agreed: “We have more belief in ourselves as a whole. Before this many of us would have struggled with creativity but The B!G Idea has helped us to grow our creativity and be more confident.”
And Teacher Michele Daly, Coláiste Iósaef Community College said of her class who had participated: “Students are becoming more independent thinkers, critical thinkers... they are using their creativity every single day in class and they’re relying on each other.”
Since it was launched four years ago, 10,000 students in 23 counties, with support from more than 1,000 industry mentors, have taken part in The B!G Idea. And we want to reach even more students.
The B!G Idea’s vision is a world where our young people, no matter what their background, have the creative thinking ability to tackle and solve the complex challenges that they will face throughout their lives. We want to democratise the teaching of creative thinking so that every young person in Ireland is empowered with this critical life skill.
The B!G Idea is FREE and open to Transition Year, Leaving Cert Applied and Northern Ireland equivalent programme students, as well as Youthreach and Community Training Centre learners.
Visit: www.thebigidea.ie for more information. Teachers can register their class or group of students online at teachers.thebigidea.ie/








RATHMINES College are ready to welcome new students to new and existing courses all starting in September ’24. The City of Dublin FET College Rathmines Campus, in the heart of Rathmines, offers courses in Professional Accountancy, Arts and Social Science, Business and Marketing, English (ESOL) and Business, Software Development, Legal Studies, Media and Office Administration.
And what also stands out when applying to Rathmines College is the course fee of just €50 for all QQI and Professional Accountancy courses, as well as our long established oneyear Repeat Leaving Certificate programme.
Starting in September Rathmines College are excited to offer a new QQI Level 5 course in Business with Sustainability Studies (5M2102) This unique course blends traditional business studies with a robust focus on sustainability, ensuring students are well-prepared for a future where ethical practices and environmental needs are paramount. This course leads to a business award that links to a wide range of courses through the CAO, including the BSc in Sustainability in UCD (DN240) and offers entry to the QQI Level 6 Advanced Business in Rathmines College.
Courses that are particularly popular for the academic year ahead are Pre-University Law, Digital News and Media alongside the great choice of Business, Marketing and Software Development courses.
Students who study in Rathmines College benefit from the vibrant learning environment, low registration fees of just €50, student supports and grants. The college also offers excellent education and employment progression opportunities following graduation.
Education progression routes include Trinity College, UCD, DCU, TU Dublin and Maynooth University with many of the students who graduated in June ’24 now on course to start exciting higher education

degrees in these universities.
A recent graduate says of the college
‘’I really enjoyed my time studying in Rathmines College, all the teachers were so supportive and helpful throughout the year. I couldn't have chosen a better place to study my QQI Level 5 and I look forward to the opportunities that come my way in the future.’’
Apart from over 30 QQI Level 4 and 5 courses, this City of Dublin FET college also offers a selection of wellestablished QQI Advanced Level 6 courses in Business, Office Administration and Software Development. Again, these are oneyear full-time courses and are an excellent way to progress to 2nd year
"I couldn't have chosen a better place to study my QQI Level 5 and I look forward to the opportunities that
in many third level colleges, for example TU Dublin, IADT and NCI.
Rathmines College has been offering a one-year Repeat Leaving Certificate for close to 45 years. With the repeat course fee of just €50 students and parents can rest assured they are getting the best value for money alongside excellent teaching experience and college resources to secure high success rates for the Leaving Certificate in June 2025.
Rathmines College is also a long established provider of Professional Accountancy courses and offers diploma programmes accredited by ACCA and ATI that equip learners to go straight into employment or progress to advanced entry to University degree programmes. The College is a founding provider of the Accounting Technicians Ireland (ATI) Apprenticeship programme.
To Go Further with Rathmines College and learn more about courses, student life and progression routes click and apply on www.rathminescollege.ie or email info@rc.cdetb.ie




THE Disability Access Route to Education (DARE) is a third level alternative admissions scheme for school leavers whose disabilities have had a negative impact on their second level education. DARE offers reduced points places to school leavers who, as a result of having a disability, have experienced additional educational challenges in second level education.
DARE is for school leavers (under 23yrs as of 1 January 2025) who have a disability and who may not be able to meet the points for their preferred course due to the impact of their disability. Applicants to DARE can present with an Irish Leaving Certificate, A-Levels and other EU qualifications.
Mature students and students applying on the basis of Further Education and Training (FET) results have different admission routes. You can get further information on these routes from college and university websites.
Is DARE for me?
If you have one or more of the disabilities listed and your disability has had a negative impact on your second level education, then you should apply to DARE. To be eligible for DARE, you must meet both the evidence of disability criteria and educational impact criteria.
If you apply to DARE and meet the application criteria (that is, are deemed eligible for DARE) you may be offered a place even if you do not have enough Leaving Certificate points for your preferred course.
Each participating college and university has a number of reserved places to offer eligible DARE applicants at lower or reduced Leaving Certificate points.
An example of a reduced points offer is that the Leaving Certificate points for a particular course is 366 points. An eligible DARE applicant
could be offered a place with a lower points score, e.g. 356 points.
This applicant would also, like all other applicants applying to college on the basis of their Leaving Certificate results, need to meet the minimum entry requirements and any specific programme requirements before being considered for a DARE reduced points offer.
The reduction in points for DARE places varies every year.
The number of points a particular course is reduced by is dependent on a number of factors, such as •The overall number of places on the course.
•The number of reserved DARE places on the course.
•The number of DARE eligible applicants competing for these reserved places.
Information on the number of reduced points places available per course and the method used by colleges for selecting eligible DARE students for those places is available on HEI websites and on each of the participating colleges’ page on the accesscollege.ie site.
If you have one or more of the disabilities listed and your disability has had a negative i mpact on your second level education, then you should apply to DARE
Eligible for both DARE & HEAR
Research has shown that students with disabilities from disadvantaged backgrounds face the greatest obstacles when it comes to progression to higher education. In order to increase the numbers of students facing this ‘double disadvantage’, colleges participating in DARE and HEAR have agreed to prioritise this group when allocating reduced points places.
You don’t have to be eligible for DARE to get support in college. All students with a verified disability, regardless of whether they come through DARE or not, can avail of a variety of academic, personal and social supports while studying at third level.
College supports may include:
• Orientation programmes.
• Learning support.
• Assistive technology.
• Library support.
• Exam accommodations.
• Educational Support Worker.
• Academic tuition.

AHEAD provides information to students and graduates with disabilities, teachers, guidance counsellors and parents on disability issues in education.
AHEAD undertake national research relating to the inclusion of students with disabilities, contribute to national policy forums and provide professional development opportunities to develop the capacity of staff in FET and higher education to be more inclusive. See www.ahead.ie.
Applying to DARE and applying for a language waiver are two separate processes. Therefore, DARE applicants who require a language waiver but haven’t yet applied for one need to apply to the relevant authorities (UG, UL, UCD, UCC, TCD, etc.).

Further information on applying for language waivers is available on the accesscollege.ie site.
If there is a language requirement in the specific programme requirements for your chosen course, you must have that language.
Students on most professional health/ teaching courses are required to complete a medical declaration form confirming they do not have a disability/ significant on-going illness that may delay or prevent them starting or completing the professional programme.
If you are applying for these type of courses, it is useful to discuss any questions or concerns you may have with the Disability/Access Service in the college in which you are interested.
Students applying to DARE are encouraged to find out more information on the maintenance grant. Additional information on other sources of financial assistance for third level students is available at www.studentfinance.ie.
Comprehensive information on the DARE scheme is available at www.accesscollege.ie
AHEAD provides information to students and graduates with disabilities, teachers, guidance counsellors and parents on disability issues in education.




"The latest development of a tertiary partnership with universities is the jewel in the crown for PLCs"
A GOLDEN Moment for PLC
Provision If ever there was a golden moment for post leaving cert provision (PLC), it is now. The congruence of different societal issues like the housing crisis, cost of living, high university drop-out rates and a new recognition of the value of PLC programmes means that PLC is enjoying its time in the sun.
For some time, PLCs were considered the poor cousins of further and higher education. Many thought of doing a PLC as a last resort - one you would do only after all higher education options were exhausted. It was the fall-back option. Many students thought there was a kind of ‘stigma’ attached to completing a PLC course. It suggested they were not good enough for university.
Better prepared
This perception has now changed. It began with a recognition by universities that PLC students were better prepared for university than their Leaving Cert compatriots. A study completed by DCU highlighted this. It compared those entering university directly from Leaving Certificate with those entering after a PLC course at level 5. The drop-out rate in first year university for those coming directly from post primary school can be up to 36%, while the drop-out rate for PLC graduates is as low as 2%. Why is this? The answer is simple.
PLC graduates are more prepared to deal with the pressures of university. PLC courses teach all the skills needed for successful study at university level like academic writing, study and research skills, referencing, time management, independent learning and IT skills. This helps ease a student into university life, feeling that they know what is expected of them.
Those who have not completed a PLC course often feel overwhelmed with the sudden drop into independent learning that is not fostered at post primary level. They also often realise that a university course is not what they had expected. Again, PLC graduates have the advantage here, having sampled their chosen course for the previous year and they can now feel certain that path is for them.
The much-publicised housing crisis has had its impact on students.
"So many
students are unsure of what they want to do, they need another year to decide, and PLC helps them do that"
Those seeking to go to university far from home often meet the accommodation barrier and many have been unable up take up a place because they couldn’t find student accommodation. Their next option is to complete a PLC which will be closer to home and will cost almost nothing in fees. Most PLCs will only charge a nominal certification fee compared to thousands at university.
Further and higher

Recognition for PLC also came in the form of a move to place further education with higher education in a separate government department. The first minister for Further and Higher Education, Simon Harris, spent much time travelling the country visiting further education settings and supporting PLC programmes. He acknowledged the important role further education plays in offering alternative routes for students and real-life training. Most PLC courses fulfil a dual role of preparing students for progression to university or into the workplace. The Minister put further education on an equal footing with higher education, no longer the poor cousin but rather one half of a partnership.
LOETB’s Tullamore Further Education and Training Centre (FETC) is capitalising on this golden time. This September the centre will increase its PLC provision by 16

courses, bringing its total number of full-time PLC programmes to 35.
Principal Irene Togher sees a real need for such provision in the county.
‘So many students are unsure of what they want to do, they need another year to decide, and PLC helps them do that. In that PLC year they can mature, learn valuable skills and be certain what path they want in university or the workplace. We also have a cohort of students who defer a university place and complete a PLC to build up skills and save for university. Education at their doorstep appeals to them and parents alike.’
The latest development of a tertiary partnership with universities is the jewel in the crown for PLCs. Under this partnership a university uses a further education centre as an out-reach centre where students can complete the first and sometimes second year of a degree locally, before completing the rest of the degree in the partner university.
Irene Togher sees huge value in this for students. ‘Students can complete a year of their degree locally, without fees, and then go directly into second or sometimes third year in the partner university. Currently our level 6 business students can progress directly into second year of certain business degrees and we are
working on a link with TUS (Technical University of the Shannon) to have the same arrangement for science. Next year we will work on broadening our partnerships with universities in the areas of computers and nursing. And the interesting thing is that universities are coming to us because they see the value of such partnerships in retaining students and getting students of a high calibre.’
Tullamore FETC will offer a wide range of PLC programmes from September 2024 and will build up its already strong links with universities. The centre already has well-estab-
"Most PLC courses fulfil a dual role of preparing students for progression to university or into the workplace"
lished departments like healthcare, computing, childcare, science and business. Some of these departments have been expanded with extra options in science, healthcare and business. New areas have been added like law, criminology, psychology, tourism and airline, art and pre-teaching. All courses can be found on www.tullamorefetc.ie/ with applications open online.
By Irene Togher, Principal, Tullamore Further Education and Training Centre



are newage requirements for General Service Recruitment intothe Irish Defence Forcesfor
Army Recruit
Naval Service Recruit
Air Corps Recruit

Applicantsmust notbe less than 18years of age and under 29 years of age atthe time of application. The Irish Defence Forces recruit Army,Air Corps, and Naval Service recruits allyear round.
Limerick
Cork
Kilkenny

2 Brigade
There are new age requirements for General Service Recruitment into the Irish Defence Forces for Army Recruit | Naval Service Recruit | Air Corps Recruit
Dublin Louth Meath
Westmeath
(Defence Forces Training Centre)
Kildare
Cork
Applicants must not be less than 18 years of age and under 29 years of age at the time of application. The Irish Defence Forces recruit Army, Air Corps, and Naval Service recruits all year round.
Donegal

Where are our units located?
ARMY UNITS
1 Brigade Galway
Kilkenny
2 Brigade
Dublin Louth Meath
Westmeath
Donegal
DFTC
(Defence Forces Training Centre)
Kildare
AIR CORPS UNITS
Dublin
NAVAL SERVICE UNITS
Cork


The Recruit Training syllabusis designed to produce physicallyfit, disciplined and motivated Two Star Privates, Naval Service Able Rates, and Air Corps Airwomen/ Airmen, with basicmilitaryskills. Recruit training is thefoundation of allmilitary training. It is approximately 12 weeksin duration. On successful completion of Recruit Training, the trained Recruit will then takeon a further 12 weeks of training intheir respective service. This training willbe specific totheir chosen service. Recruit trainingis broken down into four phases;
THE Recruit Training syllabus is designed to produce physically fit, disciplined and motivated Two Star Privates, Naval Service Able Rates, and Air Corps Airwomen/ Airmen, with basic military skills. Recruit training is the foundation of all military training.
1. Induction Period
The Recruit Training syllabusis designed to produce physicallyfit, disciplined and motivated Two Star Privates, Naval Service Able Rates, and Air Corps Airwomen/ Airmen, with basicmilitaryskills. Recruit training is thefoundation of allmilitary training. It is approximately 12 weeksin duration. On successful completion of Recruit Training, the trained Recruit will then takeon a further 12 weeks of training intheir respective service. This training willbe specific totheir chosen service. Recruit trainingis broken down into four phases;
tion Period
1. Induction Period

Introductory Training Period
Introductory Training Period
Introductory Training Period
It is approximately 12 weeks in duration. On successful completion of Recruit Training, the trained Recruit will then take on a further 12 weeks of training in their respective service. This training will be specific to their chosen service. Recruit training is broken down into four phases:
Tactical Training Period
Training Period
Tactical Training Period
Final Training Period

Final Training Period
Final Training Period













Book your free visit now!

Looking for a unique and immersive educational trip for your students?
Saint Patrick’s Cathedral offers a wide range of tours and workshops as part of our free educational programme for Irish schools.
Explore some highlights from our diverse offerings:
Music Workshop: Delve into the rich tradition of music in the Cathedral and uncover the amazing science and technology behind church organs.
60 min/Ages 9+
Medieval Workshop: Step back into the Cathedral’s origins by creating art and calligraphy as medieval scribes did hundreds of years ago.
45 min/Ages 9+
Stained Glass Workshop: Explore the history and craftsmanship of our beautiful windows and express your creativity by making your own stained glass designs.
45 mins/Ages 8+
History Tours: Take a journey through time and listen to the stories steeped within the Cathedral’s walls and the famous characters who have walked its halls.
30-45 mins/Ages 8+
This offer is available for educational groups from across the island of Ireland (exclusions apply). Contact us regarding transport support.
Book Online: spcd.ie/visit Email: schools@spcd.ie


GALWAY City Museum together with Galway City Council and Galway Education Support Centre have developed a brand new Continuing Professional Development (CPD) course for teachers.
The new course will take place at the Museum every summer in July and will cover Object-Based Learning (OBL), Place Based Learning (PBL) and Creativity in the Museum and Classroom.
By incorporating art, drama, storytelling, and digital technology, the CPD course aims to help teachers to bring the past to life for their pupils in a fun and engaging way, and in doing so improve their pupil’s ability to shape their own views and perspectives on history, heritage, culture, and art.
Teachers and pupils are invited to visit Galway City Museum where they can engage with the archaeology, history and culture of the city and enjoy spectacular views of the Claddagh and Galway Bay.
A consistent recipient of Tripadvisor’s Travellers’ Choice award, Galway City Museum is fully accredited under the Heritage Council’s Museum Standards Programme for Ireland. Guided tours of the exhibitions can be arranged in advance for school groups, free of charge.
Visiting groups can engage with the wide range of education resources available including ‘A History of Galway in Objects’. Activity sheets, art materials and research resources are available at the front desk and for download at GalwayCityMuseum.ie
The new medieval Galway exhibition, Surrounded by Stone features the story of the iconic stone monuments that mark Galway as a place of rich artistic and architectural vision and tradition, from 1100 BC to 1750 AD.
A new temporary photographic exhibition ‘Women of the Thar
The Museum has three floors of galleries housing a range of inspiring exhibitions that explore Galway’s cultural landscape and its historic relationship with the sea
Desert’ by Karen Cox will be installed for this year’s Galway International Arts Festival and will remain in place until October 2024.
The Museum has three floors of galleries housing a range of inspiring exhibitions that explore Galway’s cultural landscape and its historic relationship with the sea. Among them are Keepers of the Gael | Caomhnóirí na nGael; Revolution in Galway, 1913-23; The Galway Hooker; The Claddagh: A Triumph of Unconscious Beauty, SUPERHUMAN | FORDHAONNA and The Wild Atlantic - Sea Science.
Museum opening hours are Tuesday to Saturday, 10am – 5pm and Sunday, 12pm – 5pm (April to September). Galleries close at 4.45pm.
To get the latest news on upcoming events and activities, visit www.galwaycitymuseum.ie or follow Galway City Museum on social media. Admission is FREE! Funded by Galway City Council.























A NEW incentive scheme financially incentivises qualified plumbers who take time off work to complete Domestic Heat Pump Installation training.
From the end of July, the scheme will give plumbers a €500 cash incentive if they take time off work to upskill as SEAI registered heat pump installers.
The SEAI says that the €500 is a clear acknowledgement by the Government that while upskilling is advantageous for employees and their employers, it can be costly in terms of lost working hours.
With many homeowners now replacing their boilers with heat pumps, the training programme provides plumbers with a qualification that is in increasing demand, unlocking significant future work opportunities.
For employers, the scheme is an investment in their team, which will deliver immediate benefits.
The SEAI says that this scheme is important in helping Ireland to meet heat pump targets set out in the Climate Action Plan. These targets include the installation of 400,000 heat pumps into existing houses by 2030, with an interim target of 45,000 by 2025.
There are currently not enough heat pump installers, which is why this incentive is so important. The SEAI strongly supports this scheme’s potential to achieve an additional 300 certified and registered heat pump installers this year.
SEAI is also working with course providers, manufacturers, and installers to review the Level 6 Heat Pump Installation and Commissioning course and will advise SOLAS on any updates to be included.
THE June Wind Energy report from shows that Ireland’s wind farms provided 34 per cent of the country’s electricity in the first half of 2024.
The figures, published by Wind Energy Ireland, show that wind power generation in June 2024 was the third highest on record for a June month, totalling 771 gigawatthours (GWh).
Wind energy met 25 per
cent of Ireland’s electricity demand last month, up 5 per cent from June 2023, while solar power and other renewables provided an additional 8 per cent of our electricity.
Kerry regained its top spot as the country’s leading source of wind energy last month, accounting for 12 per cent of Ireland’s wind power at 90 GWh.
It was closely followed by Cork (82 GWh), Galway (67 GWh), Donegal (52 GWh) and Tipperary (47 GWh).


‘

‘Explore

Table 1. Number of Full -Time Stude nts in Schools Aided by the Department of Education

Class Pupils in
1. Special School enrolments include enrolments in Special Schools located in Hospitals and other settings More details, including a t ime series of the tables in this document , can be found at:
Table 2. Number of Schools Aided by the De partment of Education
https://www.gov.ie/en/publication/055810 -education-statistics/ For more information, please contact Statistics@education.gov.ie
Table 3. Number of Teaching Staff (Full -time Equivalent
Table 4. Overview of Pupil-TeacherRatio at First andSecond Level
Table 8. Enrolments of Full-Time Students
Table 4. Overview of Pupil-Teacher Ratio at First and Second Level
Only teachers paid from funds provided by the De partment of Education a re included in the above table

The pupil-teacher ratio (PTR) is calculated at each level by dividing the total number of pupils by the total number of allocated posts (classroom teachers and support teachers). This calculation differs from other such calculations (for example the staffing schedule at primary level which is the basis for allocating classroom teachers to each school based on their enrolments )
Table 5. Pupil-Teacher Ratio and Average Class Size in National Schools
The pupil-teacher ratio (PTR) is calculated at each level by dividing the total number of pupils by the total number of allocated posts (classroom teachers and support teachers). This calculation differs from other such calculations (for example the staffing schedule at primary level which is the basis for allocating classroom teachers to each school based on their enrolments ).
Total
Table 6. School Size at First and SecondLevel in2022/2023
Table 5. Pupil-Teacher Ratio and Average Class Size in National Schools
Size(Number of Pupils)
Table 6. School Size at First and Second Level in 2022/2023 Enrolment Size (Number of Pupils)
Table 7. State Examinations 2021 and 2022
Table 7. State Examinations 2021 and 2022
AONTAS - National Association of Adult Education
2nd Floor, 83/87 Main St, Ranelagh, Dublin 6.
☎ 01 4068220 www.aontas.com
The Arts Council
70 Merrion Sq, Dublin 2.
☎ 01 6180200 www.artscouncil.ie
Association of Advertisers in Ireland Ltd
120 - 121 Lower Baggot Street, Dublin D02 FD45.
☎ 01-6599457 www.aai.ie
Association of Chartered Certified Accountants
La Touche House, 1st Floor IFSC, Dublin 1.D01 R5P3.
☎ 01 447 5678 www.accaglobal.com/ie
Chambers of Commerce of Ireland
11 St Stephen's Green. D02 FY84.
☎ 01 4004300 www.chambers.ie
Association of Consulting Engineers of Ireland
46 Merrion Sqr, Dublin D02 VF66.
☎ 01 6425588 www.acei.ie
Association of Garda Sergeants & Inspectors
6th Floor, Phibsborough Tower, Dublin 7.
☎ 01 8303166 www.agsi.ie
Association of Occupational Therapists of Ireland
18 Herbert St, Grand Canal Dock, Dublin, D02 FK19.
☎ 01 874 8136 www.aoti.ie
Association of Secondary Teachers of Ireland
Thomas MacDonagh House, Dublin D08 P9V6.
☎ 01 6040160 www.asti.ie
An Bord Altranais
18/20 Carysfort Ave, Blackrock, Dublin. A94 R299
☎ 01 6398500 www.nmbi.ie
Chartered Institute of Logistics and Transport
1 Fitzwilliam Plc, Dublin 2. D02 DT68
☎ 01 6763188 www.cilt.ie
Chartered Institute of Management Accountants cimaglobal.com/ireland
Chartered Institute of Personnel & Development www.cipd.ie
Computers in Education Society of Ireland Blackrock Education Centre, Co Dublin. A96EW01. www.cesi.ie
Construction Industry Federation
Construction House, Canal Road, Dublin 6.
☎ 01 4066000 www.cif.ie
Design and Crafts Council of Ireland Castleyard, Kilkenny. R95 CAA6
☎ 056 7761804 dcci.ie
Dublin Institute for Advanced Studies
10 Burlington Road, Dublin. D04 C932.
☎ 01 6140100 www.dias.ie
Dublin Adult Learning Centre
3 Mountjoy Square, D1.
☎ 01 8787266 www.dalc.ie

Economic and Social Research Institute
Sir John Rogerson’s Quay, Dublin D02 K138.
☎ 01 8632000 www.esri.ie
Education Research Centre
DCU St. Patrick’s College, Drumcondra. D09 AN2F.
☎ 01 8373789 www.erc.ie
Engineers Ireland
22 Clyde Road, Ballsbridge, Dublin 4. D04 R3N2
☎ 01 6651300 www.engineersireland.ie
Self Help Africa Gorta
4th Floor, Joyce’s Court, 38 Talbot Street. D01 C861
☎ 01 677 8880 www.selfhelpafrica.org/ie
Honourable Society of King’s Inn
Henrietta Street, Dublin 1.
☎ 01 8744840 www.kingsinns.ie
Law Society of Ireland Blackhall Place, Dublin 7. D07 VY24. ☎ 01 6724800 www.lawsociety.ie
Accounting Technicians Ireland
47-49 Pearse Street, Dublin 2. D02 YN40 ☎ 01 649 8100 W: accountingtechniciansireland.ie
Institute of Advertising Practitioners in Ireland
Grand Canal Quay, Dublin 2. D02 CD51 ☎ 01 6765991 www.iapi.ie
The Institute of Banking IFSC, 1 North Wall Quay, Dublin 1. D01 T8Y1 ☎ 01 6116500 www.iob.ie
Institute of Certified Public Accountants in Ireland
17 Harcourt Street, Dublin 2. D02 W963 ☎ 01 4251000 www.cpaireland.ie
Chartered Accountants Ireland
Chartered Accountants House, 47 Pearse St, Dublin 2. ☎ 01 6377200 www.charteredaccountants.ie
Institute of Guidance Counsellors 17 Herbert Street, Dublin 2. ☎ 01 6761975 www.igc.ie
Institute of Professional Auctioneers & Valuers
129 Lower Baggot Street, Dublin 2.
☎ 01 6785685 www.ipav.ie
Institute of Public Administration
57/61 Lansdowne Rd, Dublin D04 TC62
☎ 01 2403600 www.ipa.ie
Institute of Industrial and Systems Engineering
8 S Circular Road, Saint Catherine's, Dublin. www.iise.ie
Insurance Institute of Ireland
5 Harbourmaster Place, IFSC, Dublin 1, D01 E7E8.
☎ 01 645 6670 www.iii.ie
Irish Association of Social Workers
114 Pearse St., Dublin 2.
☎ 086 024 1055 www.iasw.ie
Society of Chartered Surveyors Ireland
38 Merrion Square, Dublin 2. D02 EV61
☎ 01 6445500 www.scsi.ie
Irish Congress of Trade Unions
31/32 Parnell Sq, Dublin 1.
☎ 01 8897777 www.ictu.ie
Irish Council for International Students
41 Morehampton Road, Dublin 4. D04 AE28
☎ 01 6605233 internationalstudents.ie
Irish Dental Association
Unit 2, Leopardstown Office Park, Sandyford, Dublin 18. ☎ 01 2950072 www.dentist.ie
Irish Farmers Association
Irish Farm Centre, Bluebell, Dublin 12. D12 YXW5
☎ 01 4500266 www.ifa.ie
Irish Recorded Music Association
IRMA House, 1 Corrig Ave, Dun Laoghaire, Co. Dublin. www.irma.ie
Irish Fish Producers' Organisation
8 Anvil Court, Killybegs, Co Donegal. F94 YX9T. ☎ 087 7118800 www.ifpo.ie
Irish Institute of Training and Development 4 Sycamore House, Naas, Co Kildare. W91 TF95 ☎ 045 881166 www.iitd.ie
Insurance Ireland
5 Harbourmaster Place, IFSC, Dublin 1, DO1 E7E8 ☎ 01 676 1820 www.insuranceireland.eu
Irish Management Institute
Sandyford Road, Dublin 16. D16 X8C3 ☎ 01 2078400 www.imi.ie
NewsBrands Ireland
Clyde Lodge, 15 Clyde Road, Ballsbridge, Dublin 4. ☎ 01 668 9099 newsbrandsireland.ie
Irish Medical Organisation 10 Fitzwilliam Place, Dublin D02 Y322 ☎ 01 6767273 www.imo.ie
Irish National Teachers Organisation 35 Parnell Square, D1. ☎ 01 8047700 www.into.ie
Irish Nurses and Midwives Organisation The Whitworth Building, North Burnswick St, Dublin D07 NP8H ☎ 01 6640600 www.inmo.ie
Irish Pharmacy Union Butterfield House,Butterfield Ave., Dublin 14. ☎ 01 4936401 www.ipu.ie
Irish Professional Photographers Association 38/39 Fitzwilliam Square,Dublin 2. ☎ 01 401 6878 ippva.com
Irish Society of Chartered Physiotherapists 13 Adelaide Road, Dublin, D02 P950 ☎ 01 5240 931 www.iscp.ie


Irish Taxation Institute
South Block, Longboat Quay, Grand Canal Harbour, Dublin. D02 H927
☎ 01 6631700 www.taxinstitute.ie
Education and Training Boards Ireland (ETBI)
Piper's Hill, Kilcullen Road, Naas, Co Kildare
Phone: 045-901070
www.etbi.ie
Marketing Institute of Ireland
The Academy, 42 Pearse Street, Dublin 2, D02 HV59
☎ 01 2952355 www.mii.ie
Meet in Ireland
Amiens Street, Dublin 1.
☎ 01 574 1946 www.meetinireland.com
The Olympic Federation of Ireland Olympic House, National Sports Campus, Abbotstown, Dublin D15 EKH9
☎ 01 264 6440 www.olympics.ie
Pharmaceutical Society of Ireland
PSI House, Fenian Street, Dublin 2. D02 TD72
☎ 01 2184000 www.thepsi.ie
Irish Photographic Federation ✍ info@irishphoto.ie
E: @irishphotofederation www.irishphoto.ie
Dail Eireann
Leinster House, Dublin D02 XR20
☎ 01 6183000 www.oireachtas.ie
Dept of Agriculture, Food & the Marine Kildare Street. D02 WK12
☎ 01 6072000 www.gov.ie/agriculture
Department of Children, Equality, Disability, Integration and Youth
50-58 Baggot Street Lower, Dublin 2. D02 XWI4.
☎ 01 6473000 www.gov.ie/dcediy
Department of Defence Station Road, Newbridge, Co. Kildare. W12 AD93
☎ 045 492000 www.gov.ie/defence
Dept of Education
Marlborough St, Dublin D01 RC96
☎ 01 8896400 www.gov.ie/education
Department of Enterprise, Trade and Employment
23 Kildare Street, Dublin D02 TD30
☎ 01 6312121 enterprise.gov.ie
Department of Finance
Upper Merrion Street, Dublin D02 R583
☎ 01 6767571 www.gov.ie/finance
An Bord Pleanála
64 Marlborough Street, Dublin D01 V902
☎ 01 8588100 www.pleanala.ie
Central Statistics Office
Skehard Road, Cork. T12 X00E
☎ 021 4535000 www.cso.ie
Courts Service of Ireland
15/24 Phoenix Street North, Smithfield, Dublin 7.
☎ 01 8886000 www.courts.ie
Data Protection Commissioner
21 Fitzwilliam Square South, Dublin 2. D02 RD28
☎ 01 7650100 www.dataprotection.ie
Public Relations Institute of Ireland
84 Merrion Square, Dublin 2. D02 T882
☎ 01 6618004
www.prii.ie
Royal Institute of Architects of Ireland
8 Merrion Square, Dublin 2. D02YE68 ☎ 01 6761703 www.riai.ie
Teagasc
Oak Park, Carlow. R93 XE12 ☎ 059 9170200 www.teagasc.ie
Association of Optometrists Ireland
Kevin Culliton Rooms, 13 Greenmount House, Harolds Cross Rd, Dublin 6W. D6WK461 ☎ 01 453 8850 optometryireland.ie
The College of Progressive Education
Wicklow House, 84-88 South Great Georges Street
Dublin 2 D02 TX84.
☎ 01 4884300 progressivecollege.ie
Society of Actuaries in Ireland
75 Merrion Square South, Dublin 2, D02 KP92
☎ 01 634 0020 www.actuaries.ie
Society of the Irish Motor Industry
5 Upper Pembroke Street, Dublin 2.
☎ 01 6761690 www.simi.ie

Department of Foreign Affairs
Iveagh House, 80 St. Stephen’s Green, D02 VY53
☎ 01 408 2000 dfa.ie
Department of Further and Higher Education, Research, Innovation and Science
Marlborough St., D01 RC96
☎ 01 889 2448 www.gov.ie/dfheris
Department of Health
50- 58 Lwr Baggot St, D02XW14
☎ 01 6354000 www.gov.ie/health
Dept of Housing, Local Government & Heritage Custom House, Dublin. D01 W6X0
☎ 01 8882000 www.gov.ie/housing
Department of Justice
51 St Stephen’s Green, Dublin D02 HK52
☎ 01 6028202 www.gov.ie/justice
Department of Public Expenditure, NDP Delivery and Reform
Upper Merrion St, Dublin D02 R583
☎ 01 676 7571 www.gov.ie/per
Garda Siochana
Phoenix Park, Dublin D08 HN3X.
☎ 01 6660000 www.garda.ie
HEAnet
3rd Floor, North Dock 2, 93/94 North Wall Quay, Dublin D01 V8Y6
☎ 01 6609040 www.heanet.ie
Met Eireann
Glasnevin Hill, Dublin D09 Y921
☎ 01 8064200 www.met.ie
Ombudsman
6 Earlsfort Terrace, Dublin 2, D02 W773
☎ 01 639 5600 www.ombudsman.ie
Teachers Union of Ireland
73 Orwell Rd, Rathfarnham, Rathgar, Co. Dublin. D06 YP89.
☎ 01 4922588 www.tui.ie
Union of Students in Ireland
Ceann Áras na Mac Léinn
12 Shamrock Villas
Dublin 6W. D6W XH75.
☎ 01 7099300 www.usi.ie
VECSI Student Cultural Exchange Association
Scotsmans Rd, Monkstown, Cork.
☎ 0214841470 www.vecsi.com
Veterinary Ireland
13 The Courtyard, Kilcarbery Park, Nangor Road, Dublin 22. D22 XH05
☎ 01 4577976 www.veterinaryireland.ie
Vocations Ireland
AMRI Office, c/o Missionaries of Africa, Cypress Grove Road, Templeogue, Dublin. D6W YV12
☎ 01 531 0055 vocationsireland.com
Dept of Rural and Community Development
Trinity Point, 10-11 South Leinster Street. D02 EF85
☎ 01 773 6860 www.gov.ie/drcd
Department of Social Protection Store Street. Dublin 1.
☎ 01 7043000 gov.ie/welfareandwork
Dept of Environment, Climate & Communications 29/31 Adelaide Rd, Dublin 2. ☎ 01 6782000 www.gov.ie/decc
Department of the Taoiseach
Upper Merrion Street, Dublin 2.D02 R583 ☎ 01 6194000 www.gov.ie/taoiseach
Dept of Tourism, Culture, Arts, Gaeltacht, Sport and Media
23 Kildare Street, Dublin 2, D02 TD30 ☎ 01 631 3800 www.gov.ie/dtcagsm
Department of Transport Leeson Lane, Dublin 2, D02TR60. ☎ 01 670 7444 www.gov.ie/transport
Office of Public Works
Jonathan Swift Street, Trim, Co. Meath C15 NX36. ☎ 046 942 2000 www.gov.ie/opw
Passport Office
42-47, Lower Mount Street, Dublin D02 TN83
☎ 01 6711633 Ireland.ie/passports
Irish Prison Service
IDA Business Park, Ballinalee Road, Longford. ☎ 043-3335100 www.irishprisons.ie
Revenue
Dublin Castle, Dublin 2.
☎ 01 6792777 www.revenue.ie

American College Dublin
1 Merrion Square, Dublin 2. D02 NH98 ☎ 01 676 8939 www.iamu.edu
Atlantic Technological University (ATU) www.atu.ie
ATU Connemara Letterfrack. H91 AH5K | Tel: 091 742650
ATU Donegal Killybegs Shore Road. F94 DV52 | Tel: 074 918 6600
ATU Donegal Letterkenny Port Road. F92 FC93 | Tel: 074 918 6000
ATU Galway City Dublin Road. H91 T8NW | Tel: 091 753161
ATU Galway City - Wellpark Road Wellpark Road, Monivea Road, Galway | Tel: 091 770661
ATU Mayo Westport Road, Castlebar. F23 X853 | Tel: 094 - 9025700
ATU Mountbellew Co. Galway. H53WE00 | Tel: 090 9679205
ATU Sligo
Ash Lane. F91 YW50 | Tel: 071 91 55222
ATU Sligo St. Angela's Lough Gill. F91 C634 | Tel: 071 9143580
Burren College of Art Newtown Castle, Ballyvaughan, Co. Clare. ☎ 065 7077200 www.burrencollege.ie
Carlow College
College Street, Carlow, R93 A003
☎ 059 9153200 www.carlowcollege.ie
Cavan Institute
Cathedral Rd, Drumalee, Cavan, H12 E426
☎ 049 433 2633 www.cavaninstitute.ie
Church of Ireland Theological Institute Braemor Park, Dublin D14 KX24
☎ 01 492 3506 www.theologicalinstitute.ie
DCU Church of Ireland Centre
CIC Office, Dunboyne House, DCU All Hallows.
☎ 01 700 6074 www.dcu.ie/church-of-ireland-centre
DCU Institute of Education
DCU St. Patrick's Campus, Drumcondra, Co. Dublin.
☎ 01 01 700 9161 dcu.ie/instituteofeducation
Dublin Business School
13-14 Aungier Street, Dublin D02 WC04
☎ 01 4177500 www.dbs.ie
Dublin City University
Dublin 9. ☎ 01 7005000 www.dcu.ie
Dundalk Institute of Technology
Dublin Road, Dundalk, Co. Louth. A91 K584 ☎ 042 9370200 www.dkit.ie
Dun Laoghaire Inst of Art Design & Technology IADT
Kill Avenue, Dun Laoghaire, Co. Dublin. A96 KH79
☎ 01 2394000 www.iadt.ie
Maynooth University Froebel Department of Primary and Early Childhood Education
☎ 01 474 7413 www.froebel.ie
Griffith College Cork
Mews House, 62 Wellington Rd, Montenotte, Cork, T23 P5PC. ☎ 021 4507027 www.griffith.ie/cork
Griffith College Dublin
South Circular Road, Dublin DO8 VO4N ☎ 01 4150400 www.griffith.ie/dublin
Griffith College Limerick
3 Quinlan St, Limerick. V94 DK23.
☎ 061 310031 www.griffith.ie/limerick
Hibernia College
Block B, The Merrion Centre, Merrion Road, Dublin 4.
☎ 01 6610168 hiberniacollege.com
Marino Institute of Education
Griffith Avenue, D9. ☎ 01 8057700 www.mie.ie
Mary Immaculate College
South Circular Road, Limerick. ☎ 061 204300 www.mic.ul.ie
Maynooth University
Maynooth, Co. Kildare. ☎ 01 7086000 www.maynoothuniversity.ie
Milltown Institute of Theology & Philosophy
Milltown Park, Sandford Road, Ranelagh, Dublin 6. milltown-institute.ie
Munster Technological University
Cork Campus Bishopstown, Cork T12 P928
☎ 021 4326100 www.mtu.ie
Munster Technological University
Kerry Campus, Tralee, Co Kerry. V92 HD4V ☎ 066 7145600 www.mtu.ie
MTU Cork School of Music
Union Quay, Cork T12 E9HY
☎ 021 480 7310 csm.cit.ie
MTU Crawford College of Art & Design Sharman, Crawford Sreet, Cork.
☎ 021 4335222 crawford.cit.ie
National College of Art and Design
100 Thomas Street, Dublin 8. D08 K521
☎ 01 6364200 ncad.ie
National College of Ireland Mayor Street, International Financial Services Centre, D1.
☎ 01 4498500 ncirl.ie
NUI Galway
University Road, Galway. H91 TK33
☎ 091 524411 www.universityofgalway.ie
Portobello Institute
43 Dominick Street Lower, Dublin 1.
☎ 01 8920000 www.portobelloinstitute.com
Queens University Belfast
University Road, Belfast BT7 1NN
☎ 0044 2890 245133 www.qub.ac.uk
Royal College of Surgeons in Ireland
123 St. Stephens Green, D2.
☎ 01 4022100 www.rcsi.com
St Patrick’s Pontifical University Maynooth, Co. Kildare, W23 TW77
☎ 01 7083600 sppu.ie
Shannon College of Hotel Management Shannon Airport, Co. Clare. ☎ 091 497200 shannoncollege.com
South East Technological University (SETU) Main Campus, Cork Road, Waterford www.setu.ie ☎ 051 302000
SETU Carlow Kilkenny Road, Carlow. R93 V960
☎ 059 9175000 www.setu.ie
SETU Waterford Cork Road, Waterford. X91 K0EK
☎ 051 302000 www.setu.ie
Trinity College Dublin College Green, Dublin 2. D02 PN40 ☎ 01 8961000 www.tcd.ie
Technological University Dublin ☎ 01 220 5000
General Enquiries +353 1 220 5000 www.tudublin.ie
Technological University of the Shannon Midlands Campus
Dublin Road, Athlone, Co. Westmeath. ☎ 090 6468000 www.tus.ie
Technological University of the Shannon Midwest Campus
Moylish Pk, Limerick. V94 EC5T ☎ 061 293000 www.tus.ie
University College Cork College Road, Cork, T12 K8AF ☎ 021 4903000 www.ucc.ie
University College Dublin Belfield, Dublin 4. ☎ 01 7167777 www.ucd.ie
University of Limerick
National Technological Park, Limerick. V94 T9PX ☎ 061 202700 www.ul.ie
University of Ulster
Belfast/Coleraine/Jordanstown/Magee York Street, Belfast, Co. Antrim, BT15 1ED ☎ (048) 7012 3456 www.ulster.ac.uk
OTHER INSTITUTIONS
Open University in Ireland
Holbrook House, Holles Street, Dublin 2, D02 EY84 ☎ 01 678 5399 www.open.ac.uk/ireland
St. Mary’s University College 191 Falls Road, Belfast BT12 6FE, ☎ 048 90327678 www.stmarys-belfast.ac.uk
St. Nicholas Montessori College 12 Cumberland St. Dún Laoghaire, A96 HX78. ☎ 01 230 0080 www.smsi.ie
The College of Progressive Education Wicklow House, 84-88 South Great Georges Street, Dublin 2. D02 TX84.
☎ 01 4884300 progressivecollege.ie
Stranmillis University College
Stranmillis Road, Belfast. BT9 5DY. ☎ (048) 90381271 www.stran.ac.uk
BUSINESS COLLEGES
UCD Lochlann Quinn School of Business ☎ 01 716 4842 www.ucd.ie/quinn
UCD Michael Smurfit Graduate Business School Carysfort Avenue, Blackrock, Co Dublin, A94 XF34 ☎ 01 716 8934 www.smurfitschool.ie
DCU Ryan Academy Innovation Campus, DCU Alpha, Glasnevin, Dublin 11 ☎ 01-7006786
Kemmy Business School University of Limerick ☎ 061 202116 www.ul.ie/business
AGRICULTURAL COLLEGES
College of Agri, Food & Rural Enterprise (CAFRE) Enniskillen Campus, Co Fermanagh ☎ 028 6634 4853 Greenmount Campus, Co Antrim ☎ 028 9442 6601 Loughry Campus, Co Tyrone ☎ 028 8676 8101 www.cafre.ac.uk
Teagasc - Ballyhaise College Co Cavan ☎ 049 4338108 www.teagasc.ie/ballyhaise
Teagasc College of Amenity Horticulture 191 Botanic Rd, Botanic, Dublin. D09 VY63. ☎ 01 804 0201 www.teagasc.ie
Teagasc - Clonakilty Agricultural College ☎ 023 883 2500 www.teagasc.ie/clonakilty
Teagasc - Kildalton College
Co Kilkenny ☎ 051 644400 www.teagasc.ie/kildalton


Education and Training Boards Ireland (ETBI) Piper's Hill, Kilcullen Road, Naas, Co Kildare. ☎ 045-901070 / 045-901698 www.etbi.ie
Cavan & Monaghan Education & Training Board
Market Street, Monaghan, H18 W449
☎ 047 30888 www.cmetb.ie
Cork Education & Training Board
21 Lavitt's Quay, Cork, T12 HYT9
☎ 021 4907100
www.corketb.ie
City of Dublin Education & Training Board
CDETB Administrative Offices, Town Hall, 1-3 Merrion Road, Ballsbridge, Dublin 4. D04 PP46 ☎ 01 688 0614 www.cdetb.ie
Donegal Education & Training Board Administrative Offices
Ard O’Donnell Letterkenny. F92 DP98 ☎ 074 916 1600
www.donegaletb.ie
Dublin & Dun Laoghaire Education & Training Board
Administrative Offices, Belgard Square East, Tallaght, Dublin 24. D24X62W ☎ 01 452 9600
www.ddletb.ie

Galway & Roscommon Education & Training Board
An Coilear Ban, Baile Atha an Ri, Co. Galway, H18 W449
☎ 091 874 500
www.gretb.ie
Kerry Education & Training Board Centrepoint, John Joe Sheehy Road, Tralee, Co. Kerry V92 P2FE
☎ 066 712 1488 www.kerryetb.ie
Kildare & Wicklow Education & Training Board Devoy Park, Áras Chill Dara, Naas West, Naas, Co. Kildare. ☎ 045 988 000 kiwetb.ie
Kilkenny & Carlow Education & Training Board
Athy Road, Carlow
☎ 059 913 8560
www.kcetb.ie
Laois & Offaly Education & Training Board
Ridge Road, Portlaoise
☎ 057 862 1352
www.loetb.ie
Limerick & Clare Education & Training Board Marshal House, Dooradoyle Rd, Dooradoyle, Limerick, V94 HAC4 ☎ 061 442 100 www.lcetb.ie
Athlone Education Centre
Moydrum Road, Athlone, Co. Westmeath. N37 HO43
☎ 090 6420400 athloneeducationcentre.com
Blackrock Education Centre
Kill Ave., Dun Laoghaire, Co. Dublin. A96 EW01
☎ 01 2365000 www.blackrockec.ie
Carlow Education Centre
Kilkenny Road, Carlow. R93 E1X3
☎ 086 6883890 www.eccarlow.ie
Carrick-on-Shannon Education Centre, Marymount, Carrick-on-Shannon. N41 Y172
☎ 071 9620383 www.carrickedcentre.ie
Clare Education Centre
Government Buildings, Kilrush Rd, Ennis. V95 F782
☎ 065 6845500 www.clareed.ie
Ionad Múinteoirí Chonamara
Aird Thiar, Cárna, Conamara, Co. na Gaillimhe.
☎ 087 7916876 www.imchonamara.com
Cork Education Support Centre
Western Rd, Cork. T12 KC86
☎ 021 4255600 www.cesc.ie
Donegal Education Centre
Floor 2/3, Pier 1, Quay Street, Donegal. F94 A526
☎ 074 9723487 www.donegaledcentre.ie
Drumcondra Education Centre
Dublin 9. D09 C4H3
☎ 01 8576400 www.ecdrumcondra.ie
Dundalk Education Centre
www.dundalkec.ie
Dublin West Education Centre
Old Blessington Road, Tallaght, Dublin 24. D24 PX58
☎ 01 4528000 www.dwec.ie
Galway Education Centre
Cluain Mhuire, Wellpark, Galway. H91 R284 ☎ 091 745600 www.galwayec.ie
Ionad na Múinteoirí Ionad Oideachais Ghort a' Choirce
Gort A Choirce, Leitir Ceanainn, Co. Dún na nGall. ☎ 074 9165556 ✉ inmr@eircom.net
Kildare Education Centre Friary Road, Kildare Town, Co. Kildare. R51 KN66 ☎ 045 530200 www.eckildare.ie
Kilkenny Education Centre
Seville Lodge, Callan Road, Co. Kilkenny. R95 RH97 ☎ 056 7760200 www.eckilkenny.ie
Laois Education Centre
Block Road, Portlaoise, Co. Laois. R32 CP26 ☎ 057 8672400 www.laoisedcentre.ie
Limerick Education Centre
Marshal House, Dooradoyle Road, Limerick. V94 HAC4
☎ 061 585060 www.lec.ie
Mayo Education Centre
Westport Road, Castlebar, Co. Mayo. F23HX48 ☎ 094 9020700 mayoeducationcentre.ie
Monaghan Education Centre
Knockaconny, Armagh Road, Monaghan. H18 E890
☎ 047 74000 www.metc.ie
Longford & Westmeath Education & Training Board
Block A, Marlinstown Business Park, Marlinstown, Mullingar, Co. Westmeath, N91 RW96
☎ 044 934 8389
www.lwetb.ie
Louth & Meath Education & Training Board
LMETB Administrative Offices, Abbey Road, Navan, Co Meath, C15 N67E ☎ 046 906 8200 www.lmetb.ie
Mayo, Sligo & Leitrim Education & Training Board
Newtown, Garryduff, Castlebar, Co. Mayo ☎ 094 902 4188 www.msletb.ie
Tipperary Education & Training Board
Church Road, Nenagh, Co. Tipperary. E45 XD59 ☎ 067 31250 tipperary.etb.ie
Waterford & Wexford Education & Training Board
Ardcavan Business Park, Wexford, Y35 P9EA ☎ 053 9123799 wwetb.ie
Navan Education Centre
Athlumney, Navan, Co. Meath. C15 RK03 ☎ 046 9067040 www.ecnavan.ie
Sligo Education Centre
IT Sligo Campus, Ballinode, Sligo. F91 WFW9 ☎ 071 9138700 www.ecsligo.ie
Tarbert Education Centre
Comprehensive School, Tarbert, Kerry. V31 WD66
☎ 069 60005 www.tarbertesc.ie
Tipperary Education Centre
MIC, St. Patrick's Campus, Thurles. E41 C424. ☎ 086 - 6008860 www.tippec.ie
Tralee Education Centre
North Campus, Dromtacker, Tralee, Co Kerry. V92 HK52 ☎ 066 719 5000 www.edcentretralee.ie
Tuam Education Centre
St Patrick’s Primary School, Dublin Road, Co. Galway. ☎ 093 25877 www.tuamec.ie
Waterford Teachers' Centre
Newtown Road, Waterford. X91 XD98 ☎ 051 311000 www.wtc.ie
West Cork Education Centre
The Square, Dunmanway, Co Cork. P47 FH27
☎ 023 - 8856757 westcorkeducationcentre.ie
Wexford Education Centre
Milehouse Road, Enniscorthy, Co. Wexford. Y21 T271
☎ 053 91033530 www.ecwexford.ie

October 2024 mid-term break
All schools will close from Monday 28th October 2024 to 1st November 2024 inclusive.
Christmas 2024
All schools will close on Friday 20th December 2024, which will be the nal day of the school term.
All schools will re-open on Monday 6th January 2025
February 2025 mid-term break
All primary schools will close on Thursday 20th February 2025 and Friday 21st February 2025. (Primary schools may use 3 discretionary days to extend this break to an alternative option of a 5 day break for the period from Monday 17th February 2025 to Friday 21st February 2025 inclusive unless changes are required as part of contingency arrangements to make up for time lost due to unforeseen school closures.)
Post-primary schools will close from Monday 17th February 2025 to Friday 21st February 2025 inclusive unless changes are required as part of contingency arrangements to make up for time lost due to unforeseen school closures.
Where contingency arrangements are required a school authority may reduce the length of the February mid-term break by remaining open up to and including Wednesday 19th February 2025
Easter 2025
All schools will close on Friday 11th April 2025 which will be the nal day of the school term, unless changes are required as part of contingency arrangements to make up for time lost due to unforeseen school closures. Where contingency arrangements are required a school authority may reduce the length of the Easter break by remaining open up to and including Wednesday 16th April 2025
All schools will re-open on Monday 28th April 2025
Trócaire’s Development Education team have developed resources and programmes to support post primary teachers in exploring global justice with their class.
Please visit the Tree of Justice for our most up-to-date justice resources for early childhood, junior and senior primary, post primary and youth.


We also deliver a games-based learning programme called Game Changers Game changers encourages young people to engage with global justice issues by creating either board, card or digital games. It is open to young people from primary, post primary and youth settings.
Visit our website or scan the QR code to learn more.


The Right Focus is Trócaire’s documentary filmmaking programme, exploring global justice issues through the lens of short documentary films. It is aimed at young people in post primary schools and youth groups throughout Ireland who have a passion for global justice, are interested in documentary filmmaking, and want to make a difference.
Visit our website or scan QR code to learn more.

the right fo cus the right fo cus

